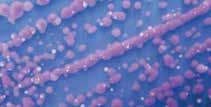

Produção, indústria e varejo: 2019 em números

Sistemas alternativos dão retorno sobre investimento?


www.seafoodbrasil.com.br

CE multiplica capturas com sombra e RN foca no espinhel para extrair joias mais valiosas


![]()
Produção, indústria e varejo: 2019 em números

Sistemas alternativos dão retorno sobre investimento?


www.seafoodbrasil.com.br

CE multiplica capturas com sombra e RN foca no espinhel para extrair joias mais valiosas


Apiscicultura brasileira deve fechar 2019 com um crescimento superior a 10%, segundo a Associação Brasileira da Piscicultura (PeixeBR) (Estatísticas, pág. 70), apoiado em novas áreas em licitação, Estados com forte atratividade para investimentos, novos modelos de produção (Direto da Produção, pág. 60) e expansão da cadeia de fornecedores de insumos e serviços. A carcinicultura vai para 90 mil toneladas de vannamei, garante a Associação Brasileira de Criadores de Camarão (ABCC). No lado da pesca, o litoral do Ceará se tornou um canteiro de obras de embarcações para a pesca do atum, enquanto o Rio Grande do Norte aposta em projetos de rastreabilidade e diferenciação (Capa, pág. 36).
A Secretaria de Aquicultura e Pesca (SAP), coordenada por Jorge Seif Jr. (Cinco Perguntas, pág. 6) promete destravar as áreas aquícolas, regulamentar a pesca ilegal (e os pescadores), atender aos pescadores de grande porte e melhorar a articulação com o Mapa, onde agora está abrigada. Um primeiro trunfo é a criação do Comitê Técnico




de Pescados, demandado pela Associação Brasileira da Indústria de Pescados (Abipesca) e apoiado por entidades como a Associação Brasileira de Fomento ao Pescado (Abrapes). O canal aberto deve melhorar o fluxo de informações e discussão técnica sobre normativas e a inspeção.
Tudo isso é extremamente positivo. Mas se a produção e a indústria destravarem como se espera, temos mercado para absorver? A feira Apas (MKT & Investimentos, pág. 14) será um bom termômetro, mas a economia nacional ainda patina e não deverá caminhar no mesmo ritmo do setor. A participação orientada pela Apex-Brasil em Boston aponta caminhos para a inserção internacional do nosso pescado, mas a falta de perspectivas para a reabertura do mercado europeu ainda é um fator desestimulante. Estamos preparados para uma demanda menor que a oferta?








Estaremos na Apas Show 2019! Visite-nos no Pavilhão Vermelho - R16

Nosso escritório administrativo fica em São Paulo/SP e todo o processo se dá em mais três unidades:
CD Ceasa/SP (11) 4612-3594 | (11) 4612-3589
CD Navegantes/SC (47) 3342-7435
CD Raposo/SP (11) 4617-5159 | (11) 4612-2439
Administrativo/SP (11) 2674-1277 | (11) 2674-2876
contato@newfish.com.br
a Jorge Seif Jr., secretário da Aquicultura e Pesca do Mapa
CONTEÚDO MULTIPLATAFORMA
Acesse nosso canal para assistir à entrevista com Jorge Seif Jr. na íntegra. youtube.com/seafoodbrasil

Armador de pesca radicado em Santa Catarina, Jorge Seif Jr. busca proximidade com setor privado e o Mapa para resgatar credibilidade da pasta
“Tenho uma dúvida muito grande: por que esta pasta sempre foi tão cobiçada? Disputei a vaga com mais de 14 pessoas, nem o Ministério da Justiça tinha tantos interessados”, ironiza o novo secretário da Aquicultura e Pesca, Jorge Seif Jr. Ele próprio não era a primeira opção: em novembro do ano passado, foi visitar pessoalmente o então candidato eleito Jair Bolsonaro, ex-colega do pai no serviço militar, e saiu de lá com o compromisso de apontar o quadro técnico de que o setor precisava. Acabou assumindo diante da recusa de nomes do empresariado e a rejeição de parte do Executivo à figura do ex-deputado federal Valdir Colatto (MDB).
Quando chegou à Brasília, disse ter se surpreendido com a qualidade dos servidores remanescentes do MPA, mas não deixou as críticas de lado. “Faltava uma sensibilidade dos gestores para conhecer, ouvir e estar atento às necessidades.” Agora do outro lado do balcão, este empresário e filho de um dos maiores armadores de pesca do País garante que os negócios privados não irão se sobrepor aos públicos. “O nosso interesse aqui não é outro que resolver os problemas da pesca [e aquicultura].”
1 A sua chegada é um exemplo da política de quadros técnicos do novo governo, mas a sua atuação na esfera privada pode gerar críticas de incompatibilidade. Como contornar isso?
Não sabia disso porque é meu primeiro cargo público na vida, mas quando você ingressa no setor público faz uma declaração indicando se tem
conflito de interesses e o que você fará para não cometer uma infração e não colocar seus interesses à frente do interesse público. Hoje estou 100% afastado das atividades da minha empresa, meu pai tem uma procuração plena e irrestrita, minhas atividades empresariais continuam. O nosso interesse aqui não é outro que resolver os problemas da pesca. Não vou decepcionar; estou com toda minha energia, todo meu coração, para dar uma resposta a esse setor maravilhoso, pujante e potente, e fazer diferente dos outros gestores até aqui.
2 O que já foi possível realizar nestes 60 dias à frente da pasta [a
entrevista foi realizada em 07 de março] e quais as metas para os 100 dias de governo Bolsonaro?
A pesca veio para dentro do Mapa em dia 25 de janeiro. Ainda estamos em transição: nomeação de pessoas, equipes novas, questões burocráticas da máquina pública, muitos servidores novos sem contato com setor público.
Com exceção destes problemas da Comunidade Europeia [veto às exportações], que são de 2017, todos os demais se arrastam por décadas. Temos apenas 2 mil barcos monitorados, mas estimamos que mais de 98 mil barcos atuem em toda a costa brasileira. Se você não mede não tem controle, não


“O Presidente da República acreditou na nossa proposta para mudar o setor aquícola e pesqueiro brasileiro. Eu sou servidor público, estou aqui para servir.”
tem arrecadação de impostos, não tem formalização do trabalho, não tem rastreabilidade, não tem controle de qualidade, não tem como divulgar o produto. Uma de nossas metas de governo é estabelecer um controle sobre o que estamos produzindo com estatística pesqueira. As gestões anteriores pararam de patrocinar as instituições de ensino, ficaram devendo mais de R$ 3 milhões, enquanto a universidades bancavam com seus próprios recursos do Governo Federal.
3 Uma das medidas adotadas neste período foi o fim da gestão compartilhada dos recursos pesqueiros com o Ibama e ICMBio. Existe alguma ameaça as ferramentas criadas neste âmbito, como os comitês de gestão?
A última coisa de que eu quero é que me acusem de ser alguém que mata e libera demais sem conservação. Os CPGs são uma herança da gestão compartilhada que iremos fortalecer. Sentamos em uma mesa com o governo, academia, setor produtivo e sociedade civil organizada para discutir diversos temas e, através deste conselho consultivo, deliberamos as mudanças entendidas como necessárias. Temos de ter uma visão 360o, ouvir a todos e fazer políticas públicas adequadas para os recursos brasileiros.
Acabou o compartilhamento porque a pesca é uma atividade de fomento. O Ibama e ICMBio são órgãos de controle
e proteção, mas não podemos controlar algo que não se conhece.
4 Com escândalos e transições constantes, inclusive dentro do Mapa, a credibilidade da pasta caiu muito. Como a ministra Tereza Cristina enxerga o setor e de que maneira está este processo de reconstrução da credibilidade?
O Mapa é o ministério riqueza do Brasil. 40% do nosso PIB passa por ele. Então quem pesca ou produz tilápia, mexilhões, tambaqui, pirarucu, carpa, panga é produtor rural e tem que ficar dentro do Mapa. A interlocução com a ministra Tereza Cristina está muito bacana; ela é uma pessoa solícita, nos atende imediatamente quando necessário, diferente da época em que a pesca passou pelo Mapa.
O Presidente da República acreditou na nossa proposta para mudar o setor aquícola e pesqueiro brasileiro. Eu sou servidor público, estou aqui para servir.
5 O Brasil tem uma participação ínfima no comércio mundial pescado. Por outro lado só não importa mais porque há restrições, como no caso do camarão. O que a SAP pode fazer para tornar o Brasil um ator relevante lá fora e conciliar interesses de importadores e produtores?
É um problema multidisciplinar. Precisamos resolver questões triviais e básicas de dentro de casa para poder pensar em outras soluções, como os problemas internos de produção e o consumo do brasileiro. Precisamos incentivar o consumo na rede pública, hospitais, escolas e universidades. É um dos projetos que iremos propor ao Congresso. As associações são grandes braços para poder fazer essa sinergia entre grandes indústrias e pequenos produtores.
[Sobre o conflito de demandas entre produtores e importadores], a questão da sanidade é indiscutível, tem de haver uma paridade. O que é exigido do produtor brasileiro tem de ser exigido para qualquer produtor de qualquer lugar do mundo, isso é uma demanda do setor da carcinicultura nacional. Estive com o presidente da ABCC, Cristiano Maia, e ele trouxe esta questão para a SDA/ Mapa. Também ouvi restaurantes que defendem a compra de camarões maiores que não estamos produzindo. Acredito que o mercado tem de se equalizar. O Brasil é um dos países mais protecionistas do mundo e o nosso Ministro Paulo Guedes tem uma visão mais liberal, precisamos nos abrir a outras nações por uma questão de competitividade e o nosso governo tem de dar condições ao produtor. Existe mercado para todos e nós precisamos trabalhar na paridade de produção, paridade sanitária e todo mundo vai ganhar.





Tecnologia para pesca e criação
A Spring Genetics e a Akvafork Genetics conduzem desde 2014 estudos de associação genômica para ambas as variedades de estreptococoses. Após uma pesquisa com técnicas de biologia molecular, descobriram mais de 16 mil marcadores genéticos distribuídos pelo genoma da tilápia. As empresas apostam agora na multiplicação de animais selecionados geneticamente pela resistência a desafios sanitários.

O mercado tem à disposição agora uma nova ferramenta contra doenças da piscicultura, como estreptococoses. A vacina autógena da AcquaAzul foi desenvolvida em parceria com a Microvet desde o final de 2017 a partir da identificação e isolamento dos agentes patógenos presentes em áreas específicas de cultivo. Por ser autógena, o Mapa exige o registro para cada produtor que a utilize.

A “assistência” aos centros de reprodução públicos e privados é o foco da Hoepers, empresa que atua há um ano na comercialização de hipófise, hormônios, testosterona, entre outros produtos. A companhia é representante exclusiva do hormônio Ovopel para a América Latina e inicia as tratativas de exportação para Colômbia, Peru e Paraguai.

com motor WEG Trifásico e pés em aço 304 inox. Já o aerador tem capacete em polietileno e cesto de proteção também é em aço inox 304. São quatro modelos disponíveis: 3/4 cv,1 cv,1,5 cv e 2.0 cv para piscicultura, carcinicultura, tanques para depuração de peixes, hapas para alevinagem de tilápia, entre outros.
Fornecedora de equipamentos para tratamento de água e efluentes, a VazFlux é parceira da empresa espanhola Pedro Gil que atua há mais de 100 anos no comércio internacional. Os sopradores tipo “roots” são frutos da sociedade, que segundo a companhia brasileira têm uma eficiência de cerca de 8% a mais em relação aos equipamentos existentes no mercado. A VazFlux garante que os equipamentos geram menores níveis de ruído e vibração nos mancais, trabalham com pressões de até 1 bar e ainda têm redução no consumo de energia.
A Induscava pensou em durabilidade com produtividade e desenvolveu o alimentador com flutuador e silo e o aerador com flutuador. Para o alimentador, a capacidade é de 250 kg, 500 kg e 800 kg



No mercado desde 2012, a Fosfish oferece alimentos completos e balanceados. Entre as ofertas está a ração para alevinos Fosfish Tilápia AL 45; Fosfish Tilápia TR 36 para crescimento e a Fosfish Tilápia TR LINE 32 exclusivo para crescimento e engorda de peixes. A linha ainda contempla outros produtos para as diversas fases do animal.





Produtos rastreáveis e padronizados
Qualidade reconhecida por diversos países
Entregas em aeroportos de todo Brasil
Frota pesqueira própria Desde




Projeção de crescimento é geral para 2019, mas principais atores moderam otimismo diante de ano de demanda tímida e ajustes no novo governo
OBrasil vive quebrando a bola de cristal dos analistas econômicos. Se no ano passado a expectativa era de uma recuperação financeira no primeiro semestre e um caminho de ascensão até as Eleições, a greve dos caminhoneiros mostrou que somos pródigos em quebrar qualquer plano de retomada. Falar em aceleração econômica neste início de 2019 também parece futurologia sem embasamento, já que o governo ainda vê dificuldades de apoio no Legislativo para encontrar uma fórmula equilibrada para a reforma da Previdência. Há sinais de impaciência do mercado financeiro e, de forma ainda mais nítida, da própria população - a julgar pela mais recente pesquisa de popularidade
da gestão Jair Bolsonaro feita pelo Ibope. Tensões entre os três Poderes continuam flagrantes e contribuem para desestabilizar o panorama.
Natural que este cenário se reflita em cautela em todos os setores, mas o pescado em particular vê isso se expressar de várias formas. As projeções de crescimento da aquicultura são otimistas: piscicultura deve subir acima de 10% e a carcinicultura 16%, de acordo com PeixeBR e a ABCC. Ambas as atividades falam em incremento das exportações, hoje irrisórias, e é nítido o esforço de grandes players para mudar este quadro, como mostrou a feira de Boston este ano. O dólar com picos de R$ 4,00 ajuda bastante na competitividade brasileira.
Na esfera doméstica, porém, os indicadores econômicos estão pouco favoráveis e há dúvidas sobre a capacidade de absorção do mercado nacional. O âmbito institucional se fortalece, com as entidades setoriais cada vez mais relevantes e atuantes na interlocução com o Estado. A criação do Comitê Técnico de Pescados dentro do Ministério da Agricultura é um segundo passo de uma articulação que teve como primeira conquista a nova Câmara Setorial da Aquicultura e Pesca. As iniciativas, somadas ao respaldo que a Secretaria de Aquicultura e Pesca sob o comando de Jorge Seif Jr. tem agora do Mapa e do próprio presidente, o setor parece enfim ter encontrado um diálogo aberto com o poder público para endereçar as questões determinantes para a evolução do setor.































A ABRAPES foi criada em 2016 para aprofundar as relações entre os entes privados e públicos, de forma a costurar soluções para o aumento da comercialização e do consumo de pescado.

Importadores, exportadores, indústrias, distribuidores, tradings e varejistas estão unidos para atingir este objetivo. Junte-se a nós!

De Rondônia ao Paraná, insumos aumentam e pressionam custos de produção, enquanto produtores se digladiam para encaixar produto no mercado
Amissão de entregar os números projetados pela PeixeBR para o fechamento de 2019 não é das mais fáceis. A ração extrusada, responsável por 70% do custo de produção da piscicultura brasileira, acompanha a alta dos seus principais ingredientes: milho e soja.
De acordo com a Companhia Nacional de Abastecimento (Conab), os preços pagos ao produtor de soja deverão subir 9% em média no Brasil na safra 2018/19, para perto de R$ 72 a saca de 60 quilos. Já a saca do milho, segundo o Cepea, subiu R$ 10 entre janeiro e março e os altos estoques do início do ano reduziram o plantio, fechando 2018 com aumento acumulado de 15,3% para acima de R$ 38.
Por outro lado, a quantidade de peixe gordo não foi compatível com
o apetite de uma economia nacional em recuperação e muitos piscicultores não puderam encaixar o produto como esperavam. Forte concorrência regional nos pólos produtores, como São Paulo, Minas Gerais, Vale do São Francisco, Paraná e até Rondônia, que antes reinava soberana na região Norte, impactaram a atividade.
O diretor de projetos da Biofish Consultoria, Jenner Menezes, vê uma piora sensível entre 2018 e este ano na piscicultura de Rondônia. “Tem relação com o crescimento da atividade em RR, nosso principal concorrente para o mercado amazonense, e pela queda no preço da tilápia - que baixou também o valor do produto para o mercado Sudeste, Sul, Centro-Oeste e parte do Nordeste.” Além disso, Mato Grosso e Tocantins também aumentaram a produção. “Isso de certa forma nos represa.”
Menezes considera que a abertura do frigorífico Pescados do Vale, em Ariquemes (RO), que tem registro no SIF, possibilita mais oportunidades para o peixe regional. Outro frigorífico “sifado” está em fase final de instalação em Itapuã Do Oeste (Rondofish) e deve colaborar para escoar peixe beneficiado a outras praças e fugir desta competição pelo inteiro à região Norte.
O custo de produção também não colabora na disputa. Segundo o consultor, a ração balanceada extrusada de 28% PB com 10mm varia entre R$ 35 e R$ 38. Demais itens como os alevinos, mão de obra, energia elétrica, minerais, combustíveis e taxas também estão mais altos nos primeiros meses do ano.
Carro-chefe da região, os tambaquis de 2-2,2/kg eram vendidos em fevereiro
a R$ 5,20 e os maiores (3-3,5 kg) para o mercado de Manaus entre R$ 6,00 e R$ 6,30/kg. A margem para o produtor é de 25% a 35% dependendo do sistema de produção e controle da tecnologia de produção. Os exemplares grandes vão para Manaus e Porto Velho, enquanto o tambaqui de padrão 2-2,2 kg seguem ao Centro Oeste, Sudeste, Sul e Nordeste. Híbridos como pintado da amazônia, tambatingas e outras espécies vão para o Centro Oeste, Norte e Nordeste, mesmo destino do pirarucus e piaus.
A exportação também é um canal, embora seja menos seguro do ponto de vista da constância. Há demanda de pirapitinga e tambatinga para o Peru em torno de 80 toneladas mensais, mas os produtores só atendem parcialmente
Alevinagem de tilápia pode sofrer diminuição de volumes com ajustes na engorda
a oferta por uma “fragilidade de mercado e inconstância de compra”. Para ele, há “receio dos aquicultores em criar a espécie específica para aquele mercado e não conseguir venda em seguida”. Há produtos que saem clandestinamente pelo Acre para atender à demanda, segundo Menezes, principalmente após a paralisação das operações da Peixes da Amazônia, que entrou em Recuperação Judicial.
Se a concorrência é grande nos nativos, pode-se dizer que é gigante na tilápia - as 400 mil toneladas produzidas em 2018 representam mais que todas as demais espécies somadas. Uma mudança na dinâmica dos insumos, portanto, afeta na mesma

medida o negócio. Na região do vale do rio São Francisco, em Paulo Afonso (BA), a ração chega a representar 75% do custo de produção atual. Segundo o presidente da Associação de Aquicultura do Rio São Francisco (PeixeSF), Anttonio Almeida Júnior, o saco de 25 kg sai R$ 47
A produção na Bahia chega a um custo médio final de R$ 4,60 kg, com


a margem do produtor variando de R$ 0,70 a R$ 0,90 por kg de pescado vendido na fazenda, o que representa 15% a 20% do preço final. O mercado não anda muito favorável por conta da entrada do peixe de outros centros, principalmente Minas Gerais, para disputar o mercado nordestino. A situação tem segurado o preço e provocado baixa remuneração do setor. A expectativa do presidente, entrevistado em fevereiro, era que a situação melhorasse no período da Quaresma.
Há outro revés que já prejudica a cadeia local: a proliferação de baronesas, ou aguapés. Estas plantas aquáticas são um indicativo da poluição proveniente do despejo de esgoto nos reservatórios e afetam de Petrolina (PE) a Paulo Afonso (BA). Só no reservatório do Moxotó, de acordo com a PeixeSF, oito pisciculturas fecharam por conta da proliferação da planta, que em excesso disputa oxigênio com os peixes. Uma audiência pública marcada para o fim de março na Bahia discutiria o tema.
A líder nacional da tilapicultura também sofre com os insumos. O professor Ricardo Pereira Ribeiro, da Universidade Estadual de Maringá
(UEM), diz que o maior impacto é nas fases iniciais. As rações de primeira alevinagem correspondem a cerca de 6% da ração consumida no ciclo de produção. “São as mais caras de todas e custam atualmente entre R$ 4,70 a R$ 5,70/kg”, comentou. Para a fase seguinte o custo médio é de R$ 3,00/kg e o maior volume consumido está concentrado na ração de 32% de proteína com granulometria de 6 mm a 8 mm.
Há uma clara diferença entre o Norte e o Oeste do Estado, segundo o professor. No Oeste há mais diversidade de fornecedores de alevinos e preços entre R$ 90 e R$ 120, enquanto no Norte fica entre R$ 120 a R$ 160. Pelo custo dos insumos e diferenças no modelo de produção, as pisciculturas de pequena escala em viveiros escavados ou tanques-rede nos reservatórios do rio Paranapanema são menos competitivas que as pisciculturas integradas às cooperativas. Segundo Ribeiro, o custo de produção médio do kg de tilápia no Norte, na faixa de R$ 4,57, praticamente se equilibra ou supera o preço de venda, enquanto no Oeste fica em torno de R$ 3,74.
Na esfera da comercialização, notase uma redução na compra do peixe gordo desde maio de 2018. A partir
de janeiro deste ano, conforme indica o professor, os estoques se reduzem em todas as regiões do Estado, com exceção dos clusters das cooperativas. “Essa retração não foi observada entre os produtores integrados da Copacol e C-Vale, as quais, apesar da retração dos mercado varejista, mantiveram suas políticas de expansão da produção e continuaram suas operações de abate e povoamento normalmente”, completou. Os preços no Norte do Paraná para peixes gordos estão entre R$ 4,20 e R$ 4,50/kg e no Oeste de R$ 3,80 e R$ 4,00/kg.
O pólo compartilhado por Aparecida do Taboado (MS) e Santa Fé do Sul (SP) também deve assistir a uma dinâmica similar à de Rondônia. Com medo da queda na demanda e nos preços, produtores de pequena escala povoaram menos, enquanto Geneseas, Tilabras e Ambar Amaral seguem investindo em tecnologia para melhorar a produtividade.
“Precisamos reduzir custo e vamos investir muito em máquina e equipamento”, garante o diretor da Ambar, Ramon Amaral. É um caminho para combater o marasmo de 2018. “Foi o pior ano para a aquicultura nestes 11 anos em que estou na atividade”, indica, apontando o excesso de oferta
como fator primordial. Juliano Kubitza, gerente geral da Royal Fish, tem a mesma sensação, mas vê um ajuste em curso. “Creio que esse ano difícil pode repercutir em um melhor equilíbrio entre oferta e procura ao longo de 2019, fazendo o produtor voltar a ter rentabilidade e alguma alta de preços ao consumidor.”
A Quaresma em meados de abril ajuda muito. Segundo o diretor da Peixe Vivo Piscicultura, Emerson Esteves, os estoques de peixes acima de 1kg já rarearam até março e o preço para a Ceagesp estava por volta de R$ 4,40 em meados do mês. A expectativa dele era a de que o preço dos exemplares maiores subisse para R$ 4,80 com a proximidade da Semana Santa. “Outros mercados já estão pagando mais, na faixa de R$ 4,60 a R$ 4,70”, diz.
Alimentador automático da Geneseas: investimento em tecnologia para diminuir custos e aumentar eficiência será a tônica de 2019
Os fornecedores agradecem. A assistente técnica e comercial da Spring Genetics, Micaele Sales , o movimento do mercado sinaliza recuperação já no fim de março e reversão da tendência de muita oferta e preços baixos. ”Nas últimas semanas pudemos perceber o contrário e com a chegada de quaresma esperamos que haja uma ascensão de preços no consumidor final, e que seja distribuído na cadeia de comercialização”. No médio prazo, otimismo, evidenciado pelo comentário de Kubitza. “Acredito muito na possibilidade de atingirmos um patamar de consumo de tilápia, ao longo dos próximos anos, da ordem de pelo menos 5 kg por habitante por ano. Isso representa 1 milhão de toneladas de peixes e estamos falando apenas de mercado interno. ”



O secretário da Aquicultura e Pesca, Jorge Seif Jr., confirmou a participação na abertura da 10ª Aquishow Brasil, entre 14 e 17 de maio, em Santa Fé do Sul (SP). Além de conhecer in loco o maior evento de piscicultura de água doce da América Latina, Seif Jr. poderá acompanhar a iniciativa da organização de extrapolar o contexto de negócios para criar uma experiência mais ampla. “Queremos criar memórias afetivas para quem dela participar. Elaboramos uma série de interações para se tornar uma experiência no aspecto profissional e pessoal. Quando a Aquishow acabar, queremos que as pessoas já tenham saudade e já se comprometam a vir em 2020”, confidencia Marilsa Fernandes, diretora da PeixeSP e responsável pela feira. Como consequência, a organização preparou diversos eventos paralelos. Uma das principais novidades é o Prêmio Inovação Aquícola
2019, fruto de um esforço conjunto da feira com as mídias Aquaculture Brasil e Seafood Brasil. O prêmio pretende reconhecer as principais iniciativas que contribuem para o desenvolvimento da cadeia produtiva aquícola no País. Esta primeira edição recebeu 46 inscrições de todo o Brasil, nas categorias Academia; Produção; Beneficiamento; Produto final e Políticas Institucionais.
Além do prêmio e o tradicional programa de palestras, a Aquishow 2019 terá ainda o lançamento do Torneio Filetador de Ouro, que pretende descobrir o profissional capaz de obter o melhor rendimento de carcaça em menor tempo. Completam ainda a programação o Master


Criação de Comitê Técnico de Pescados sacramenta acolhida do Mapa ao setor e amplia canal para discussão de normativas
Aindústria brasileira do pescado estima um aporte de R$ 1,2 bilhão este ano em ampliação e construção de novas unidades industriais, enquanto o faturamento deverá subir 11% na comparação ao ano passado, quando a receita superou R$ 10 bilhões. Os dados são da Associação Brasileira da Indústria de Pescado (Abipesca), para quem essas nem são as informações mais relevantes do setor no ano.
O destaque do segmento em 2019 é a criação do Comitê Técnico de Pescados no âmbito da Secretaria de Defesa Agropecuária e da Secretaria da Aquicultura e Pesca do Ministério da Agricultura. A instituição deste fórum
consultivo foi sacramentada pela publicação no Diário Oficial da União, em 20 de março, mas a discussão que o gerou começou muito antes.
Na edição #18 da Seafood Brasil, mostramos o processo de reestruturação do Departamento de Inspeção de Produtos de Origem Animal (Dipoa), em 2016, que, entre outras medidas, extinguiu as divisões especializadas, como o Departamento de Inspeção de Pescados (Dipes) com o pretexto de que todos os servidores eram capazes de fazer avaliações técnicas.
Na avaliação da Abipesca, a prática trouxe uma consequência paradoxal ao longo dos últimos dois anos: os temas
relativos ao setor passaram a ser endereçados aos próprios técnicos egressos do Dipes. “Grande parte dos expedientes relativos ao nosso setor (...) tem tido em apenas um, ou no máximo dois representantes da estrutura, a análise e resposta aos pleitos setoriais”, disse o então presidente da entidade, Thiago De Luca, em comunicado enviado ao novo secretário de Defesa Agropecuária, José Guilherme Leal, em 30 de janeiro de 2019.
Esta questão foi levada em audiência de 16 de janeiro ao próprio Leal, que estimulou um expediente da Abipesca para a criação de uma estrutura heterogênea, multidisciplinar e com representantes técnicos, científicos e comerciais da esfera
pública, privada e da sociedade civil. O apoio de outras entidades, como a Associação Brasileira de Fomento ao Pescado (Abrapes), fortaleceu o pleito. Assim surgiu o Comitê, que funcionará como uma espécie de braço consultivo da Câmara Setorial de Pescado - criada, por sua vez, no ano passado.
O secretário-adjunto da SDA, Fernando Augusto Pereira Mendes, também vê a iniciativa com bons olhos. “A publicação da portaria pelo Mapa é um sinal claro de reconhecimento da importância e do potencial do setor pesqueiro e aquícola na economia do País.” Para ele, o segmento agora ocupa um “espaço nobre” na pasta. “Iniciativas de inovação e modernização do segmento poderão ser alavancadas com maior qualidade e em menor tempo, graças a uma maior articulação entre setor público e privado.”
Passarão a fazer parte da pauta do comitê, por exemplo, a elaboração dos regulamentos técnicos de identidade e qualidade, normativas relacionadas ao uso de aditivos e ingredientes, critérios para enquadramento de empresas no Regime de Alerta de Importação (RAI), a harmonização de regulamentos com análogos internacionais, entre outros temas.
Só o tempo dirá se o Comitê, que se pretende exclusivamente técnico, irá pacificar as relações entre fiscalizados e fiscalizadores, mas a repercussão até aqui sinaliza uma vitória coletiva. “Vemos que é uma forma muito democrática e compatível com o momento que o Brasil está vivendo”, ressaltou o secretário Jorge Seif Jr., ele próprio um industrial
Algumas destas discussões já faziam parte de expedientes anteriores, para os quais o setor já havia encon-
trado boa receptividade. Um exemplo é a harmonização, pelo Dipoa, de todos os itens da lista de aditivos permitidos pelo novo RIISPOA, em parceria com a Anvisa. Os órgãos já preparam um documento que será colocado em Consulta Pública em breve. “A minuta foi antecipada para nós e há restrições de uso de aditivos com a justificativa de uso tecnológico. Do ponto de vista de saúde humana não haveria problema, mas o Mapa tem muito receio da fraude, é uma forma de eles limitarem isso”, indica Thamires Quinhões, diretora-executiva da Abrapes.
Mesmo que a Instrução Normativa decorrente desta Consulta Pública não contemple os aditivos desejados pelo setor, novas inserções poderão ser solicitadas. Bastará fazer um peticionamento para inclusão de um aditivo, com uma justificativa tecnológica clara daquele produto. As atualizações


periódicas acontecerão mais de uma vez ao ano. “A minuta atende a mais do que 50%, mas não contempla todos os aditivos que o setor gostaria”, sublinha Quinhões.
Outra questão central é a demora na emissão de Licenças de Importação (LI’s), que em 2018 chegaram a esperar mais de 70 dias. Em 13 de fevereiro, o Dipoa apresentou o novo sistema eletrônico de requerimento para autorização de importação. A exigência de recorrer ao Serviço de Inspeção de Produtos de Origem Animal (Sipoa) persiste, mas não mais no papel. A anuência do Mapa não é mais vinculada à localização da empresa, porém ao número de pessoas em cada Sipoa. “Quando o importador protocola o pedido não sabe aonde irá parar, mas pode acompanhar pelo sistema a tramitação”, explica Quinhões. Outra novidade é a mudança da concessão de embarque para autorização de importação. Ou seja, o importador pode determinar o despacho e conseguir a autorização no caminho.
O novo sistema surge para garantir a estimativa de 30 dias, que é o prazo legal, mas também deve acabar com um efeito colateral da burocracia:
“Como o maior problema é com pescado fresco, as pessoas acabam pedindo por precaução mais do que serão utilizadas”, ressalta a diretora da Abrapes. Segundo o Mapa, só 33% das LI’s solicitadas virou importação efetiva; só um importador entrou com 400 pedidos.
Enquanto a discussão institucional se aprofunda com o novo fórum, as indústrias buscam inovações que não dependam de novas normativas. É o caso da Noronha, que pretende criar no Brasil uma categoria de produto amplamente difundida mundo afora: o bloco de peixe. O item já foi apresentado no fim do ano passado em coquetel do Alaska Seafood Marketing Institute (ASMI), entretanto a empresa de Recife (PE) é a primeira a apostar nele.
No mundo inteiro o bloco de polaca é vendido como matéria-prima para se desenvolver outros produtos de valor agregado. Oferece vantagens logísticas e de padrão, peso e formato. É justamente esta a ideia do diretor, Guilherme Blanke. “Trazemos os blocos de 7kg de polaca e o cortamos ainda congelado, sem nenhum tempero ou processo
industrial. Agora queremos ensinar o consumidor a preparar em casa.”
A empresa conta com a ajuda da ASMI e fornecedores como a Trident Seafoods para desenvolver receitas e pretende atacar também o food service, além do varejo, com um posicionamento superior aos filés brancos sem espinha por conta do congelamento único feito no Estado norte-americano. Filés brancos de outras origens são congelados a bordo, descongelados na indústria para filetagem e recongelados. “É uma categoria acima dos filés, principalmente para canais que precisam de cortes de peixe branco com padronização de tamanho e sem risco de espinhas, como hospitais, creches, restaurantes”, sublinha Blanke.
A novidade deve ajudar a empresa a cumprir o ambicioso plano de aumentar 20% em vendas sobre um ano em que já havia registrado expansão de 20%. “Estamos mantendo um crescimento de vendas estável nos últimos sete anos, mas há dois anos estávamos com crescimento menor”, diz o empresário. Retrato da estagnação econômica do País no passado recente, que ainda persiste e pode afetar categorias das quais o setor se tornou muito dependente, como o salmão.
Para diminuir a sensibilidade às frequentes oscilações do peixe chileno, Blanke também foi ao Alasca. Hoje o salmão selvagem congelado desta origem representa 70% das suas vendas. “O Chile está há meses tentando aumentar os preços, mas o Brasil não estava suportando. Hoje o preço está entre US$ 6,70 e US$ 7.” Ele não vê o brasileiro com condições de suportar o aumento. “Temos frango muito barato e um filé de salmão entrando com preço 50% mais caro que um filé mignon.”
Para o consultor Jenaro Correa Silva, que até fevereiro era executivo da Los Fiordos, realmente houve um aumento de US$ 0,50 no preço do salmão já no primeiro bimestre do ano. “Isso seguiu conforme os preços internacionais. Esperávamos que a demanda seguiria firme, mas as chuvas e o carnaval restringiram, havia muitos




estoques em fevereiro e os valores subiram.” Só que a proliferação de algas nocivas voltou a acontecer e a amedrontar as salmoneiras: em meados de março mais de 130 toneladas de peixes morreram em um centro da Camanchaca em Chiloé.
A China volta às compras agora em março, após o Ano Novo chinês, e os Estados Unidos devem seguir estáveis. “Os preços no segundo trimestre devem se manter entre US$ 6,70 a US$ 7/kg para H/O (com cabeça) tamanho 10/12”, diz Correa, para quem as características dos peixes que estão entrando nas indústrias agora são favoráveis aos principais mercados, incluindo o brasileiro. “O peso médio está em 5,2 kg, o que oferece uma boa ponderação no mix para atender às exigências de Brasil, EUA e China.”
Há um máxima corrente no varejo segundo a qual este é o setor que sente por último os efeitos de uma crise econômica e é o primeiro a se recuperar. Os resultados preliminares do ranking da Associação Brasileira de Supermercados (Abras) e a revista SuperHiper, divulgado sempre junto à Apas Show, corroboram o dito. Os supermercados brasileiros faturaram R$ 355,7 bilhões em 2018, um crescimento nominal – sem descontar a inflação - de 0,7% ante 2017 (R$ 353,2 bilhões). A 42ª edição da pesquisa indica ainda que o segmento representou 5,2% do Produto Interno Bruto (PIB) no ano passado.
A preparação para a Semana Santa já capturava um pouco deste otimismo entre as principais redes. O Assaí, bandeira do GPA, estimava um aumento de vendas de itens de pescado; só para
o bacalhau a projeção era de vender 15% mais este ano. Já o Carrefour não se arriscou em um número, mas previa maior diversificação de produtos e apresentações para expandir as vendas além do tradicional bacalhau. “Atualmente, o Carrefour dispõe de 45 tipos de pescado fresco e mais de 30 tipos de congelados em suas lojas, com destaque para espécies brasileiras. Temos boas perspectivas para a Quaresma deste ano, quando o sortimento de pescados e frutos do mar será reforçado”, garante Rodrigo de Mattos Teixeira, diretor de peixaria da rede francesa no Brasil.
A data da feira, entre 06 a 09 de maio, complicou os planos de participação de muitas empresas internacionais do pescado por coincidir com a Seafood Expo Global, em Bruxelas. Até o fechamento desta edição, a Seafood Brasil
contabilizou 40 estandes com pescado, porém em realizações anteriores este número já chegou a 60 - cerca de 10% da feira. Pavilhões internacionais, como o do Equador e o do Peru, terão menos representantes do setor. Chile e Argentina contarão com apenas três expositores cada (veja mapa completo na página seguinte).
No caso dos equatorianos, é uma questão de privilegiar outros mercados estáveis, já que ainda paira desconfiança de exportadores e importadores sobre a manutenção do mercado aberto no Brasil para o vannamei estrangeiro. A reportagem apurou que há um fluxo constante de envio de amostras, cotações e até viagens de brasileiros ao Equador para tratar de camarão, desde a reabertura determinada pelo ministro do STF, Dias
Toffoli, no fim do ano passado. Mas o receio de perder um contêiner no meio do caminho impede a concretização de negócios. “Até 28 de fevereiro não se embarcou nada ao Brasil. Creio que há uma desconfiança que pouco a pouco irá desaparecer”, avalia o consultor Alfonso Alava, da Alfatún.
Sem o Brasil, a carcinicultura equatoriana continua em franca expansão. Só no mês de fevereiro o país exportou 45.293 toneladas, com a Ásia comprando 66,8% deste volume. A projeção de produção para este supera as 510 mil toneladas, segundo a Câmara Nacional da Aquicultura (CNA). Depois do Ano Novo chinês, os preços estão em baixa: em meados de março, a cauda do camarão 36/40 com casca era vendido a US$ 6,97/kg. Na porta das fazendas brasileiras, o mesmo cama-
rão inteiro informal sai por R$14/kg no Ceará e Rio Grande do Norte, enquanto em Pernambuco e na Paraíba passa de R$ 20. No mercado formal, o tamanho é vendido às indústrias por R$ 26 na comporta.
No âmbito nacional, o negócio começa a acelerar aos poucos. A previsão da ABCC de fechar o ano com 90 mil toneladas. A maior produtora nacional, a Potiporã, é uma das que prevê crescimento dos volumes, de 5 mil toneladas em 2018 para 7 mil toneladas em 2019. A maior parte disso encaixado no food service e distribuidores que operam com este segmento, segundo a diretora comercial, Christianny Maia. “De 2017 para 2018 tivemos um crescimento no faturamento de 34%. Para 2019, esperamos um crescimento de 40% do faturamento.”


6 A 9 DE MAIO DE 2019 EXPO CENTER NORTE - SÃO PAULO (SP)
ÁREA DE EXPOSIÇÃO : 35.552 M2
Navegue entre os peixinhos do mapa e as tabelas acima para encontrar as empresas que ofertarão pescado na Apas Show 2019. Serão ao menos 40 empresas com pescado no estande. Acesse www.apasshow.com.br para informações mais atualizadas.

1 235 Bom Porto C/7
# Estande Nome Local Produtos Pavilhão CINZA
2 210 Master Boi A/6
3 202 Fênix Alimentos B/6
Bacalhau em diferentes apresentações
Bacalhau, camarão, salmão, cioba, corvina, sardinha, polaca etc
Filés congelados, postas e produtos processados de pescado na marca Magic Fish
4 119 ASMI B/2 Oferta de peixes do Alasca
5 484 Ferraz & Ferreira J/20 Processados com bacalhau
6 450 Plena Alimentos H/18 Filés congelados
7 444 Di Salerno I/18 Conservas e salgas
8 432 Casa Flora I/17 Bacalhau
422 / 393 / 472 Argentina (Fundación Exportar) G/11>15
9 Congelados Ártico
Emapanados e pratos prontos de pescado
Linha de peixes, crustáceos
Salmão, truta
PisciSeafood Ltda Moluscos, salmão e merluza negra
Salmones Blumar Salmão e truta
322 Riberalves J/7 Bacalhau em diferentes apresentações
Data da planta: 31/03/2019
Sujeita a alterações até o dia do evento


No momento em que Real favorece exportação e produção se expande, plano de ação para reabertura é rechaçado pela UE e força busca de outros mercados
Os fatores domésticos nunca foram tão favoráveis à expansão das exportações de pescado como agora. Dólar forte e estável com Real barato, diversificação e aumento da oferta nacional, além de fortalecimento institucional para participação em feiras internacionais. No cenário externo, a guerra comercial entre China e EUA abre muitas oportunidades. Só que a fórmula não fecha: o mercado mais tradicional para as nossas vendas externas permanece fechado após um ano de suspensão auto-imposta pelo Mapa.
Conforme apurou a Seafood Brasil, o plano de ação proposto pelo ministério para reabertura da fronteira ao pescado brasileiro e enviado à Comissão Europeia não foi bem recebido. Das 9 recomendações, 6 propostas
resolutivas foram rechaçadas. “Em 29 de março, o Mapa enviou um novo Plano apresentando à União Europeia uma proposta híbrida de certificação pública e privada para embarcações sem SIF, na expectativa de aceitação em função da definição de uma única autoridade competente desde a incorporação da SAP na estrutura do MAPA”, conta Christiano Lobo, diretor para assuntos governamentais da Abipesca.
A notícia é um banho de água fria às empresas que esperavam retomar os embarques em 2019. Se um novo plano de ação for aprovado ainda este ano, a União Europeia tem de enviar uma missão sanitária ao Brasil para constatar a aplicação que, apenas para seu planejamento, não costuma tardar menos que seis meses.
Com a UE fora do baralho, todas as atenções se voltaram à Seafood Expo North America, em Boston (EUA). A Apex-Brasil garantiu novamente a montagem de um pavilhão brasileiro, que reuniu 10 empresas: Seabev International, Cais do Atlântico, Da Fonte Aquicultura, Piscicultura Cristalina, Sea Premium, Lake’s Fish, Zaltana, Produmar, Greenfish Brasil, Allmare
A feira ainda viu grande circulação de brasileiros nos corredores e também em estandes de parceiros locais, como a Geneseas, que expôs seus produtos no estande da parceira e distribuidora Tropical Aquaculture Products. “Foi uma ação para mostrar a origem da tilápia brasileira, passamos vídeos, uma geladeira com os nossos produtos e eles deram bastante destaque à Geneseas”, conta Tito Lívio Capobianco, fundador e sócio da empresa
O executivo vê uma retomada da busca por tilápia fresca de qualidade superior, já que nos últimos anos o produto chinês congelado inundou o mercado norte-americano. “Como consequência, a tilápia nos EUA começou a ser vista como produto de baixa qualidade. Queremos mostrar a qualidade da tilápia fresca das Américas, para retomar e distinguir a tilápia boa da ruim.” De fato, segundo o último relatório da associação National Fisheries Institute (NFI), o consumo da espécie caiu 8,5% em 2017 sobre o ano anterior.
As vendas de filé de tilápia brasileira aos norte-americanos continuam muito pequenas e ainda caíram em 2018: 443,173 toneladas, 26% a menos que em 2017. A análise dos dois primeiros meses do ano não indica nenhuma retomada: se em 2018 exportamos 165,2 toneladas aos EUA, em janeiro e fevereiro deste ano despachamos apenas 72,9 toneladas. Há uma tentativa clara de diversificação de mercados, que não ocorreu no ano passado, com envios de amostras do filé à Alemanha, Libéria, Hong Kong e Cingapura.
O Brasil está competitivo e estes números certamente serão maiores em 2019. Esta é a avaliação de Francisco

Medeiros, diretor-presidente da PeixeBR. “Neste momento, o preço do nosso filé está bastante competitivo, 10% mais baixo que os concorrentes da América Central e do Sul.” Segundo ele, agora é preciso buscar parcerias para encaixar o produto. “Precisamos arrumar parceiros americanos, distribuidores e grandes compradores para entrar no negócio com grandes volumes.”
A aquicultura pode ter um bom caminho pela frente, mas o que ainda faz o Brasil ser um ator minimamente relevante no exterior é a captura. A exportação de pescado nacional faturou US$ 250,66 milhões em 2018 e o prin-
cipal item da pauta ainda é a lagosta congelada, com 1.288.876 toneladas despachadas aos EUA no ano passado.
E o apetite prossegue, conforme a percepção de Arimar Filho, diretor da Produmar. “A procura por lagosta está muito grande, mas fizemos muitos contatos com compradores de peixe fresco.” A empresa opera com vários peixes costeiros com saída nos EUA, como guaiuba, saramonete, budião e ariocó e estima ampliar as vendas com os leads abertos no evento. Ele lembra também que já dominamos os EUA no mercado de atum fresco big eye, mas isto é assunto para a reportagem de Capa.

Com a União Europeia fechada para importações, as atenções se voltaram no início deste ano para a Seafood Expo North America, em Boston (EUA). Entre 17 e 19 de março, 10 empresas brasileiras participaram do pavilhão brasileiro montado pela Apex-Brasil, que contou com a presença ininterrupta do secretário da aquicultura e pesca, Jorge Seif Jr.




Alberto Bicca e Márcio Coimbra (Apex-Brasil) e Francisco Medeiros
Gustavo Bozano, Paola Abrão e Raul Lima (Lake’s Fish)
Lincoln Dubiela e Thiago Nogueira (Independent Brazil)
Mauro Nakata e Natália Nakata (Piscicultura Cristalina)




J.L Martins Jr. (Greenfish), Murilo Melo (Norte Mar) e Lucas Martins (Greenfish)
Natalia Da Fonte e Ricardo Da Fonte (Da Fonte Aquicultura)




Benvenutti e Francisco
Arimar Filho (Produmar) e Jorge Seif Jr. (SAP/Mapa)
Daniel Grijalva e Raphael Salcedo (Independent Brazil)
Roberto Imai (Imai Pesca) e Tito Lívio Capobianco Jr. (Geneseas)



A BAITAFRIO Armazém Logístico é uma ideia visionária dos irmãos ORTEGA. Desde 2012, quando pensaram em aumentar seus espaços de armazenagem, identificaram uma demanda provocada pela estagnação da economia: as dificuldades de vendas somadas à alta produção e as margens já muito apertadas tornavam a busca por armazenagem inevitável.
Foi em 2016 que, com local definido e adquirido, foi fincada a primeira estaca.
A seleção do local obedeceu a um critério fundamental para o sucesso dos parceiros da BAITAFRIO. A proximidade da Avenida do Estado, em São Paulo, corredor com ligações ao Rodoanel e à Marginal Tietê.
TECNOLOGIA
Com fornecedores e profissionais de alta qualidade recrutados mundo afora, a BAITAFRIO tem 18.000m² de terreno e mais 5.000m² de área construída. O galpão usa 100% de sua área utilizável de armazenagem, totalmente preenchida com estantes móveis, que propicia mobilidade, agilidade e aproveitamento com um volume de 6.000 posições pallets.
Esteiras de entradas rápidas automáticas customizadas proporcionam liberdade de movimentação e descarregamento nas docas automáticas de 90 pallets/h, ou seja, 03 containers/h.
Com um sistema inteligente implementado em suas CLP’s [software de controle], portas de clausuras automáticas se intercalam na abertura e fechamento e impedem a troca térmica entre os ambientes,


mantendo o padrão de temperatura na antecâmara e câmaras. Toda a gestão do estoque do armazém ocorre por software (WMS).
Para não desperdiçar energia e não perder desempenho, a empresa investiu em equipamentos de alta performance individuais, que asseguram a qualidade do frio necessário para os padrões e normas exigidos.
Em cada bloco de armazenagem, a quantidade de evaporadores e condensadores é 20% superior ao necessário, ratificando a eficiência do processo.
Vale ressaltar a utilização da mais alta tecnologia disponível no mercado, tomando como exemplo os painéis antichamas, que atendem todas as normas de segurança, além de garantir excelência em qualidade e desempenho.
Marcio Ortega Diretor Comercial

Tecnologia em processamento de pescado
Sem desperdício de carne
A linha de removedores de pele e couro semiautomáticos da Marel foi criada para retirar a pele de peixes com escamas ou de couro liso sem perda de carne valiosa. O objetivo é maximizar a eficiência do operador, aumentar a produtividade e reduzir significativamente o tempo de inatividade para limpeza.

Versatilidade na automação
Com equipamentos que vão desde a recepção do peixe até o congelamento, a Brusinox agora apresenta três novas soluções: evisceradora de sardinha laje que corta a cabeça, cauda, eviscera e

até espalma; o descamador de tilápias, que funciona por um jato d’água com alta pressão, pro movido por bom bas e ajustado para cada tamanho de peixe; e a filetadora automática para tilápias, que funciona por múltiplos discos de corte que separam os dois filés da carcaça - esta pode ir automaticamente para a máquina de CMS.



Duo lambari
A Branco Máquinas reforça sua aposta no processamento do lambari com o novo Kit Lambari 25, composto por duas máquinas. Uma descamadeira, do modelo Fish Scaler 25, e uma evisceradora 25 prometem produção hora de 25 kg/ dia a 35 kg/dia.

A linha de poliamidas de embalagens da BASF, a Ultramid, tem estrutura coextrusada (em 5, 7 ou em até 9 camadas), pode ser laminada ou não, e
busca conferir aumento de performance como barreira ao oxigênio, alta termoformabilidade para filmes fundo flexíveis e semirrígido, barreira ao aroma – importante para produtos defumados –, alta resistência mecânica e térmica –essencial para produtos esterilizados ou autoclavados –, além de alta resistência à migração de gordura, adequada ao pescado gorduroso.

Executivos da Targ Logística e Nativ fundiram experiências para criar a Frezze, um operador logístico que contrata armazenagem e carros em grande escala. “Os carros são compartilhados entre diversas empresas, barateando o custo”, conta o sócio, Pedro Furlan. Uma plataforma on-line gerencia o processo e dá rastreabilidade para as entregas mais pulverizadas nas grandes capitais.






CONTEÚDO MULTIPLATAFORMA
Acompanhe os vídeos desta viagem em nosso canal: youtube.com/seafoodbrasil


Pesca de sombra no Nordeste dá novo impulso à pesca de atuns e afins, mas explosão desordenada da frota gera oferta superior à demanda e motiva armadores de espinhel a buscar diferenciação
Texto e fotos: Ricardo Torres*
Sob a luz do luar, a tripulação de 10 pessoas faz um lance. Mais de 1200 anzóis com isca de lula jogados a 520 milhas de Natal (RN). A linha tem 100 km de comprimento. É uma boa noite de pescaria de espinhel. O barco de 20 metros faz uma trajetória circular em busca do fim da linha, içada por um carretel norte-americano. Sobem a bordo 100 peixes, a maior parte ainda vivos. Albacora-laje (yellowfin) e albacora-bandolim (bigeye), mas sempre acompanha uma pequena parcela de meca (espadarte). Cada peixe que sobe a bordo é insensibilizado em um tanque com gelo e eviscerado em uma mesa criada especialmente para isso. Depois segue para o porão climatizado, onde são engavetados no gelo.
Sob a luz do luar, a tripulação de 7 pessoas faz um lance. Um anzol com isca artificial é jogado por vez a 520 milhas de Natal (RN). A linha tem 2 metros para peixes menores e até 300 metros para exemplares maiores milhas de comprimento. É uma boa noite de pescaria de sombra. O barco de 13 metros faz uma trajetória circular em velocidade lenta para atrair os cardumes. A tripulação puxa a linha no braço. Sobem a bordo um peixe atrás do outro. Além da laje e bandolim, um pouco de bonito-listrado. A evisceração dos peixes acontece no próprio convés. Depois segue para o porão climatizado.
O recurso é o mesmo: cardumes migratórios em trânsito pelo Arquipélago de São Pedro e São Paulo, que estende nossa Zona Econômica Exclusiva (ZEE) para 520 milhas na ponta nordeste do País, além das 200 milhas estabelecidas pela Convenção das Nações Unidas para o Direito do Mar. A arte de pesca, porém, faz toda a diferença. A pesca de espinhel, cujos desembarques se concentram principalmente em Natal (RN), opera com cerca de 40
barcos dotados de tecnologia espanho la e norte-americana para trazer atuns maiores, alguns superiores a 90 kg. O objetivo é trazer poucos exemplares a bordo e conservá-los o melhor possível para vendê-los frescos ao exigente mercado nacional e internacional do sashimi.
Nos Estados Unidos, o Brasil já é a principal origem de bandolim com folga, segundo um levantamento rea lizado por Rodrigo Hazin, diretor da Nortepesca. Do total de 3,1 mil tonela das importadas pelos norte-america nos, 26,5% têm as indústrias brasileiras como origem. O market-share cresce: de 19,8% em 2016, passamos a 22,2% em 2017 e chegamos a 26,5% em 2018. No mesmo período, houve uma redução na oferta global de 24,1%, já que nossos principais concorrentesPolinésia Francesa, Suriname, Ilhas Marshall e o Equador - não têm conseguido expandir os volumes.

Na laje não somos tão competitivos. O volume exportado pelo Brasil em 2017 para os EUA (444.358 kg) situou o País na 14ª posição entre os 15 maiores players para esta espécie. Estamos atrás de Sri-Lanka, Filipinas, Ilhas Maldivas, Trinidad & Tobago, Venezuela, entre outros 15 competidores globais que despacharam 16,2 mil toneladas de laje fresca aos EUA.
Já a pesca de sombra, ou de cardume associado, é uma arte que nasceu no Espírito Santo há cerca de cinco anos e se propagou pelo Ceará e o oeste do Rio Grande do Norte como um rastilho de pólvora. Diante da ociosidade com o defeso da lagosta, pescadores começaram a direcionar seus esforços à rentável pesca do atum. Com cliente certo - basicamente a indústria de conservas Robinson Crusoe -, esta pesca explodiu. Só em fevereiro, quando nossa equipe visitou a região, especialistas que trabalham na

coleta de dados sobre esta modalidade estimavam uma frota de 250 barcos desembarcando só no Porto dos Barcos de Itarema, de onde se despacha o maior volume desta captura.
O cardume associado cresceu para volumes impressionantes. Conforme o ex-secretário da Agricultura e Pesca do Ceará, Euvaldo Bringel, relatou ao Diário do Nordeste, 62% do volume do pescado no País desta arte de pesca. Se o Brasil produziu 27 mil toneladas no ano passado, em torno de 17 mil vieram da sombra.
Como os volumes do espinhel crescem com ritmo menos intenso, foi a pesca de sombra que trouxe o Brasil de volta ao acirrado garimpo internacional do atum do Atlântico. Não por casualidade, portanto, as tensões no mar cresceram na mesma proporção.
É emblemático o caso da embarcação chinesa superior a 40 metros que deliberadamente se chocou com o atuneiro Oceano Pesca I, metade do tamanho, em 22 de novembro de 2018. Ambos estavam a 420 milhas da costa brasileira, em águas internacionais, e a tripulação temeu pela própria vida, mas o capitão conseguiu levar o barco de volta a Natal.
A ocasião gerou uma onda de fortes reações dos espinheleiros, que até hoje cobram uma posição enfática do governo brasileiro ao que consideram “uma guerra pelo atum”. Gabriel Calzavara, presidente do Sindicato da Indústria de Pesca do Rio Grande do Norte (Sindipesca), chegou a dizer que as tripulações teriam que começar a embarcar armadas. Para ele, esta é uma das consequências da disputa por cotas de captura entre países costei-
ros do Atlântico Sul (leia mais sobre a participação do Brasil no ICCAT nas próximas páginas).
Barcos chineses e até de outras origens são vistos com frequência próximos à nossa ZEE. Há relatos de que alguns ingressam ilegalmente no nosso território estendido para capturar um estoque de maiores profundidades para o qual não temos a tecnologia necessária, como a albacora-branca (Thunnus alalunga). “O Brasil está desaforando este recurso”, opina Roberto Imai, diretor titular adjunto do Departamento do Agronegócio (Deagro) da Fiesp e pioneiro do atum no Brasil.
* O jornalista viajou e se hospedou em Fortaleza (CE) e Natal (RN) a convite do Sindicato da Indústria de Pesca do Rio Grande do Norte
A captura dos atuns e afins no Atlântico Sul é regida por uma organização internacional denominada Comissão Internacional para a Conservação do Atum Atlântico (CICAA/ICCAT). Por meio de pesquisas científicas conduzidas pelos países que exploram este recurso, como o Brasil, a comissão atribui cotas de captura de forma a evitar a sobreexplotação do recurso. Veja as principais espécies capturadas pelos barcos brasileiros e o que determina a ICCAT para cada uma delas.

Big eye
(albacora-bandolim, Thunnus obesus)
Produção nacional em 2017: 7.258 toneladas
Cota no ICCAT: Não temos, mas ativamos gatilho de 3.500 toneladas
TAC (Captura Máxima Permitida): 65 mil toneladas
(deve ser reduzida para algo entre 55 mil e 60 mil)

(albacora-laje, Thunnus albacares)
Produção nacional: 20 mil toneladas
Cota no ICCAT: Não temos.
TAC: 110 mil toneladas (deve ser reduzida)

Skipjack
(Bonito-listrado, Katsuwonus pelamis)
Produção nacional: 18 mil toneladas
Cota no ICCAT: Não temos TAC para o oeste do Atlântico Sul: Não tem (não é considerada uma espécie em sobrepesca), mas o rendimento máximo sustentável é de 32 mil toneladas
Ilustrações: FAO/ONU.
Fontes: SCRS/ICCAT, Fabio Hazin, Paulo Travassos e Rodrigo Hazin

(Albacora-branca, Thunnus alalunga)
Produção nacional: toneladas
Cota no ICCAT: 2.610 toneladas
TAC: 24 mil toneladas

Meca (Espadarte, Xiphias gladius)
Produção nacional: 2.900 toneladas
Cota no ICCAT: 3.940 toneladas
TAC para o Atlântico Sul: 14.000 toneladas



No mapa é possível ver a distribuição geográfica das capturas de albacoras-bandolim (esquerda) e albacoras-laje (direita), por tipo de pesca, no período de 2010-2016, segundo a ICCAT. Os atuns do Atlântico são capturados majoritariamente entre a costa brasileira e a costa africana, em águas internacionais. Um dos principais pontos fica próximo ao Arquipélago São Pedro e São Paulo, a 500 milhas de Natal (RN).
Se o Brasil hoje faz parte do seleto grupo de competidores no mercado mundial do atum deve muito aos que hoje são alguns de seus principais concorrentes atuais, como japoneses, espanhóis, chineses e até ao nosso maior cliente, os Estados Unidos. Profissionais e embarcações destes países formaram gerações de brasileiros aptos a operar com diversas técnicas e os credenciou a elaborar suas próprias técnicas, como a pesca de sombra.

Houve ao menos três ondas de participação de embarcações estrangeiras com atuação em nossa costa. Em busca de melhores condições de vida após a Segunda Guerra Mundial, os japoneses foram os primeiros. Na década de 1960, algumas empresas nipônicas decidiram explorar os recursos do Atlântico Sul com embarcações próprias. O governo brasileiro criou a Superintendência do Desenvolvimento da Pesca (Sudepe) e, com ela, uma política pesqueira de valorização da soberania nacional.
Por paradoxal que pareça, atrair barcos estrangeiros era uma estratégia de ocupação e defesa da nossa costa. Foi neste contexto em que a Taiyo, uma potência pesqueira à época, enviou Ushimatsu Imai, um jovem recém-contratado, para desbravar a pesca no Brasil. Ele partiu direto para Santos
(SP) em um barco pesqueiro, deixando esposa e duas filhas em Hiroshima. Rapidamente, porém, ele percebeu que logo poderia repatriar todo mundo.
Se hoje o alto mar tem baixa exploração de nossos barcos pesqueiros, nesta época o mar era praticamente virgem. “Um dos conterrâneos do meu pai pescou, em frente a Salvador (BA), 200 peças de atum bluefin (Thunnus thynnus) de 200 kg em média cada um”, lembra Roberto Imai, filho do pioneiro Ushimatsu. Nascido no Brasil, ele acompanhou a trajetória de ascensão e queda deste primeiro movimento de embarcações estrangeiras.
Quanto à captura não havia problemas, mas a logística e a conservação de cargas tão caras quanto volumosas tinham deficiências graves. Os desembarques aconteciam primordialmente em Santos (SP) e Cabedelo (PB), mas não havia outros pontos. Sem um mercado consolidado, as embarcações maiores nacionalizadas foram, aos poucos, desativadas. Parelhas dedicadas à captura de peixes costeiros permaneceram, mas a Taiyo resolveu deixar o Brasil.
Ushimatsu e outros conterrâneos, porém, não desistiram. Na época, havia mais duas empresas pesqueiras conduzidas por japoneses: Olinda, com cinco embarcações, e a Kawai Suisan, com seis barcos. Ele montou a Imai Pesca e comprou três embarcações. Com a saída da matriz, adquiriu também a
indústria da Taiyo em Santos. Como estes barcos pescavam em toda a costa brasileira, os conhecimentos foram transmitidos aos poucos e estimularam novos entrantes, como a Leal Santos, de Rio Grande (RS) hoje parte do grupo espanhol Actemsa e praticante da modalidade de vara e isca viva.
As tripulações haviam passado por capacitação em centros técnicos de formação pesqueira no Japão e não abriam muito os segredos. Só que os brasileiros, que ainda pescavam apenas com sextante e bússola, começavam a reparar nas técnicas orientais para superar as próprias limitações. “Só se pescava com visão da costa”, conta Imai. O espinhel, ou longline, introduziu a linha multifilamento ideal para profundidades maiores. Os nomes das espécies em japonês, como kihada e meca (mekajiki), se popularizaram a partir desta época e duram até hoje.
Os sistemas japoneses foram aprimorados ao longo de 20 anos, mas foi só na década de 1990 que o setor viu um salto produtivo,, com a chegada de mestres norte-americanos e espanhóis e a segunda grande onda de embarcações com tecnologia estrangeira. A linha multifilamento deu lugar ao monofilamento, puxado por carretéis. Os anzóis baixaram de 1800 para 1000 e a tripulação passou de 18 para 6 pessoas.
A partir de Santos, depois Itajaí e Rio Grande (RS), com a Torquato Pon-
tes e indústrias como Pescal, a captura explodiu por todo o País. O foco era no espadarte, mas deu muito certo com os atuns. O Nordeste também entrou de cabeça: a Nortepesca, hoje sediada em Natal (RN), começou a bancar a adaptação de barcos com material importado. “Trouxemos barcos de Fortaleza e Belém e instalamos os carretéis. Chegamos a ter 25 barcos pescando para nós”, relembra o diretor, Rodrigo Hazin. Em pouco tempo o País chegou 40 embarcações e o Brasil inverteu a balança comercial do pescado pela primeira - e última - vez, tornando-se exportador de pescado.
Na esteira deste sucesso na captura, o Brasil começou a fazer parte de fóruns internacionais. Um empresário paraibano que atuava na pesca de meca foi acompanhar, como representante setorial, um painel da Comissão Internacional para a Conservação do Atum Atlântico (CICAA/ICCAT) em Washington. “Fiquei impressionado com a dimensão e importância do evento e, ao final, quando os países membros escolhem o país onde se realizará a reunião,
sugeri ao chefe da delegação brasileira que oferecesse o Brasil”, resgata Gabriel Calzavara, atual presidente do Sindipesca-RN e diretor da Norpeixe.
O economista depois se tornaria o diretor do Departamento de Pesca e Aquicultura (DPA) do Ministério da Agricultura no segundo governo FHC, criado a partir de uma cisão com o Ibama - que até então era a representação institucional do segmento. Calzavara resgatou a concepção de arrendamento e regulamentou a prática com prazos e contrapartidas definidas. “A política de ocupação da ZEE tinha dois objetivos: a difusão de tecnologia, como aconteceu com o espinhel pelágico para o atum e o espadarte; e a pesquisa dos recursos demersais abaixo de 100 metros de profundidade, como aconteceu nas pescarias do peixe-sapo, camarão carabineiro e caranguejo real.” Em última análise, o arrendamento se inseria em uma estratégia mais ampla de fazer o Brasil brigar por cotas com os outros países que pescavam no Atlântico Sul - cujo critério era exclusivamente o histórico de capturas.

Fabio Hazin, da UFRPE e presidente da seção 4 do ICCAT: “a partir de 1998, Brasil liderou um processo de revisão de práticas da comissão que tornou mais justa a política de cotas”


iberconsa de argentina s.a. (54-280) 4453088 ventas@iberconsa.com.ar www. iberconsa .es

Basicamente, a interpretação era a de que o arrendamento poderia criar histórico para o Brasil de forma mais acelerada, por conta das tecnologias mais avançadas dos barcos estrangeiros. Isso gerou forte reação dentro da própria indústria pesqueira, pois alguns armadores nacionais viam nisso uma tentativa de tirar a frota nacional do jogo dos atuns e afins, que teria capacidade de capturar este recurso.

Os barcos afinal ingressaram no País e Calzavara, que já tinha um sócio espanhol e embarcações estrangeiras, foi acusado de se beneficiar da política. Ele rechaça. “Eu já era armador, meu interesse era usar o arrendamento como um instrumento de desenvolvimento para todo o Brasil.” Ele indica que o arrendamento já existia na época do Ibama, mas não havia nenhum acompanhamento destas embarcações estrangeiras para fins estatísticos e científicos. Essa foi uma das principais inovações propostas para a terceira fase de barcos construídos no exterior.
Para definir os critérios e estabelecer os controles das novas pescarias, Calzavara aponta que o DPA criou instrumentos estratégicos, utilizados ate hoje: 1) Os Comitês de Gestão Permanente (CPGs), dotado de um subcomitê científico que analisava e recomendava limites, áreas, espécies, esforço e tipos de barco autorizados; 2) Obrigatoriedade da presença de ob-
Gabriel Calzavara ao lado do Kinei Maru Nº 108, barco dotado de ultracongeladores a -60ºC: duas embarcações do gênero estão paradas por processo judicial que se arrasta há cinco anos
servadores de bordo selecionados por universidades conveniadas; 3) Obrigatoriedade de rastreador de satélite nas embarcações; e 4) Convênio com universidades para acompanhamento das pescarias e estudos dos recursos pesqueiros - objeto das pescarias.
Este trabalho até hoje tem participação direta de uma equipe da Universidade Federal Rural de Pernambuco (UFRPE) coordenada atualmente pelo professor Paulo Travassos. A coleta e sistematização de dados iniciada na virada do milênio possibilitou uma discussão técnica no âmbito dos então recém-criados CPGs a respeito dos estoques que prossegue até a atualidade.
Mais do que isso, a credibilidade do monitoramento a bordo e a atuação decisiva de Fabio Hazin na ICCAT colocaram o Brasil em uma posição de líder entre os emergentes participantes do fórum. “O Brasil foi protagonista e liderou este processo de modernização para atualizar as práticas de definição de cotas”, sublinha o cientista, com doutorado em Tóquio, pós-doc em Miami e especializado em Direito Internacional do Mar. É primo de Rodrigo, mas sempre preferiu a carreira acadêmica.
Amparado na Convenção das Nações Unidas sobre o Direito do Mar e o Acordo de Nova York, os brasileiros costuraram um conjunto de 27 novos critérios além das capturas históricas, finalmente aprovados em uma reunião no Marrocos em 2001.
Um deles previa que as capturas pertenciam não mais à bandeira da embarcação, mas ao país aos quais os barcos estavam arrendados. A Espanha logo percebeu a “manobra” brasileira, como conta Calzavara, e publicou um decreto dacroniano. “Em 24 horas os barcos que pesquem em países costeiros do Atlântico Sul deveriam retornar, sob pena de não renovar as licenças de pesca concedidas pelo governo es-
panhol”, conta. Muitos destes estavam arrendados a empresas brasileiras. Outros países costeiros, que ao longo do século passado venderam permissões para navios com bandeira internacional também passaram a poder fazer suas próprias “cotas históricas”.
É fácil entender como o Brasil logo se tornou o parceiro de países como África do Sul, Gabão e Marrocos. A primeira conquista prática foi o aumento das cotas brasileiras para espadarte, que saíram de 2.340 toneladas em 1997 para 4.720 em 2006. O prejuízo prático foi a proibição do arrendamento de embarcações da União Europeia, que também adotou barreiras não tarifárias, como exames de histamina para exportação com uma tecnologia - cromatografia líquida de alta performance - que não detínhamos.
Apesar das embarcações e da projeção com a ICCAT, a verdade é que até 2010 o Brasil nunca havia sido uma grande potência atuneira. Com exceção do bonito-listrado, cujo estoque não é considerado sobrexplotado pelo órgão e dispensa discussões de cotas, as capturas sempre foram tímidas. “Exceto por alguns anos em que crescemos na albacora-branca em razão do arrendamento, laje e bandolim sempre foram bastante tímidas no contexto dos montantes produzidos por outras nações”, avalia Hazin.
Em 2010, segundo os dados brasileiros reportados à ICCAT, a produção de bandolim foi de 1.170 toneladas, enquanto na laje foi de 3.700 toneladas. A situação começou a mudar a partir de 2010, em razão da disseminação da pesca de sombra. Ela estabelece um novo patamar e, consequentemente, coloca o Brasil em nova dinâmica de negociação. “Aumentamos isso na ordem de seis vezes e, no momento em que o estoque está sobrepescado, os países que dispõem de cotas de captura são forçados a reduzir suas capturas”, esclarece o cientista.
Por isso o jogo de xadrez chega a um momento decisivo. A normativa em vigor na ICCAT estabelece que se um país ultrapassa 3.500 toneladas de bandolim ele está obrigado a negociar cotas. “Tentamos fazer isso ao longo de 2018, sem sucesso.” Nada indica que em 2019 seja mais fácil. Dificilmente os países pesqueiros tradicionais, como os da UE, Japão e China cederão parte de suas cotas para o Brasil praticar esta pesca. “O Brasil, por sua vez, não aceita cota menor que a sua captura atual.”
O professor Travassos, da UFRPE, alerta para outro grave problema. Desde 2010, o Brasil não tem um trabalho sistemático de coleta de estatísticas de captura. Ao longo dos últimos 8 anos, para poder manter o CPG funcionando e subsidiando o ICCAT, o trabalho foi terceirizado a entidades como a UFRPE e a Univali, de Santa Catarina, que não deveriam ter esta atribuição. *Em 2017, farto da situação, o subcomi-
tê científico apresentou uma renúncia coletiva, como forma de pressionar a [então] Seap a retomar a coleta*. Naquela época surtiu efeito.
O então secretário Dayvson Franklin de Souza conseguiu liberar orçamento para retomar as pesquisas e garantiu o aporte para o ICCAT naquele ano, evitando um vexame na reunião de novembro de 2018. “Só que a retomada de uma coleta sistemática de dados, prometida por ele, não aconteceu”, conta Paulo Travassos. A consequência poderá ser desastrosa para a próxima reunião, em novembro deste ano, justamente quando a redução das cotas de captura da albacora bandolim e albacora laje estão em jogo.
Sair do fórum não é uma opção, conforme o entendimento de Hazin, que atualmente preside o painel 4 do órgão, focado nos tubarões, agulhões
e afins. “Não somos obrigados a participar da ICCAT, mas a respeitar as condições previstas pelo órgão, sob pena de o Brasil ser considerado abrigo de pesca ilegal.”
Como consequência, mais restrições à exportação de produtos pesqueiros brasileiros e descrédito da comunidade internacional.
Como forma de transmitir responsabilidade com os estoques, Hazin defende a permanência do aporte de dados e informações sobre o ordenamento desta pesca em ascensão. Calzavara, porém, enxerga uma alternativa. Com o estoque cada vez mais controlado e as condições laborais fiscalizadas pela Organização Internacional do Trabalho (OIT), um navio já não tem a possibilidade de contratar uma tripulação barata para ficar dois anos fora de casa. “Europeus e japoneses querem o peixe, não estão mais tão interessados na pesca.” O Brasil está.




Em torno de 90% do volume de big eye e yellowfin exportados aos Estados Unidos passam de alguma forma pelas empresas sediadas na famosa Rua Chile, no bairro da Ribeira, em Natal. Praticamente todo este atum é capturado pela pesca de espinhel de superfície, criada pelos norteamericanos para a pesca do espadarte em profundidades de 50 a 80 metros. Para capturar o atum, as pescarias passaram a ser coordenadas com a lua cheia, quando os integrantes da cadeia trófica sobem à superfície em busca de alimento.
Na pesca de espinhel de superfície praticada atualmente pelos barcos que desembarcam na região, uma linha primária (ou madre) monofilamento horizontal de 50 milhas abriga diversas linhas secundárias verticais com anzois circulares e iscas nobres, como a lula, colocados a cada 5 mil metros. Bóias rádio (com GPS) facilitam a
localização no caso de rompimento. Em cada viagem, que dura em média 20 dias, a tripulação com 10 pessoas faz 15 lances entre a lua crescente e a minguante. De 1000 anzóis, apenas 100 são fisgados. Carretéis importados puxam os peixes a bordo.
A distância entre os anzóis é suficiente para a tripulação içar o peixe, insensibilizá-lo e eviscerá-lo antes que o próximo venha para o convés. A técnica facilitou a manipulação a bordo e otimizou as embarcações, que já não procuram lotar o porão com peixes, mas valorizar cada indivíduo para vendê-lo mais caro depois. Um peixe de espinhel, além de ter condição de disputar até o mercado japonês, tem preço de venda em São Paulo que pode chegar a 20 vezes o valor do peixe de sombra vendido para a indústria conserveira.
Ao tornar a operação mais eficiente do ponto de vista econômico, o espinhel também melhorou a sustentabilidade destas capturas. A intro-
dução do anzol circular, hoje uma lei federal, praticamente eliminou dois grandes problemas: os danos à fauna acompanhante e à integridade física dos peixes. O Projeto Tamar monitora e incentiva o uso há mais de uma década, entre Itajaí e Natal, e garante que a captura incidental diminui em 60%. A indústria também aprova. “O anzol circular não captura tartarugas ou albatrozes. Já o peixe engole a isca, mas é fisgado pela boca. Fica com 50 metros de linha para nadar e se movimentar”, conta Gabriel Calzavara.
O impacto para a qualidade da carne foi imediato. O atum é conhecido por ser um fenômeno da hidrodinâmica, com cardumes navegando muitas vezes em velocidades superiores a 90 km/h. Com todo esse potencial de “briga”, antigo anzol “J”, muitas vezes ficava preso ao estômago e rasgava todas as entranhas do animal, matando-o antes de ser içado a bordo. O mesmo acontecia com a fauna acompanhante. É por isso que usá-lo hoje configura crime ambiental.
Outro diferencial é a rastreabilidade. Com as técnicas de monitoramento trazidas pelos observadores de bordo, cada peixe leva um selo. Hoje é possível saber em qual dia determinado peixe foi capturado, em que latitude, longitude, se estava vivo ou morto e a temperatura em que subiu. Com a expansão do apetite norte-americano, os espinheleiros querem vender melhor estes atributos. “Queremos trabalhar a certificação deste atum”, antecipa Rodrigo Hazin. “Precisamos fazer um trabalho melhor dessa marca Brasil, além de trabalhar outras apresentações com valor agregado, porque só exportamos o HG.”
O sonho é trazer ao Brasil técnicas adotadas no Japão, como o atum superfrozen - congelado a -60ºC antes do rigor mortis, o que dá um shelf-li-
fe de dois anos. A possibilidade de estocar um peixe de tanta qualidade significa controlar melhor os preços e é tão sedutora a ponto de sustentar um plano ambicioso entre a Atlântico Tuna, de Calzavara, e a Nortepesca, de Rodrigo Hazin. Divulgado em 2011, o plano consistia em nacionalizar 8 barcos japoneses fresqueiros e 12 supercongeladores, já tinha clientes no Japão e o financiamento necessário. O primeiro barco em operação, Kinsai Maru Nº 58, mostrou o potencial da captura. Depois de dois anos de operação, chegou ao auge em agosto de 2013, quando capturou 195 toneladas com espinhel multifilamento.
A carga nunca chegou a Natal. Foi retida em Salvador (BA) por fiscais do Ibama que detectaram irregularidades do toriline (linha
espanta-pássaro) e na distância entre os anzóis da linha secundária. Calzavara garante que o equipamento havia sido aprovado previamente por uma consultoria contratada pelos empresários justamente para respeitar a legislação brasileira. caso foi à Justiça e, após uma vitória do armador na primeira instância, com pagamento de multa de R$ 1,5 milhão, o Tribunal Regional Federal da 1ª Região (TRF1) julgou procedente o recurso da Advocacia-Geral da União (AGU) e reverteu a decisão. O caso desmotivou a continuidade da empreitada e, até hoje, os dois barcos japoneses estão se deteriorando na área do Terminal Pesqueiro de Natal - por sua vez também desativado. Mas assim como sugere o nome informal do projeto de atum supercongelado - Lázaro -, Calzavara e Hazin ainda querem ressuscitá-lo.




Dia cheio em Itarema (CE). Em meados de fevereiro, em torno de 50 barcos estão atracados no Porto. Um deles está terminando de descarregar 15 toneladas de laje e bandolim, levados por jovens carregadores até o caminhão frigorífico da Brother Pesca Há peixes entre 30 kg e 50 kg, mas outros claramente menores. Muitos não haviam sido eviscerados.
Na extremidade esquerda do Porto, a Braga Pescados funciona a todo vapor. A maior fornecedora de gelo na região nunca viu tanto movimento. A fábrica de gelo para terceiros é um serviço extra da empresa, que sempre teve barcos para lagosta - atividade mais complexa e refém dos períodos de defeso. “Entramos no atum por ser uma pescaria que não exige tanta despesa, pois leva menos ma-
terial. É só linha e isca, não precisamos de manzuá ou outros equipamentos”, explica o armador Werly César Braga Couto. Eles foram os pioneiros em Itarema, inspirados pela captura crescente do atum em Camocim (CE).
No começo, faziam troça. “Nosso primeiro barco, o Marlin, saiu com o equipamento da pesca de cardume, boias e luzes. Saiu sem destino, sem cardume, e voltou com 3 atuns.” No Porto, não perdoaram. “Ninguém botava fé, só tiravam sarro.” Na segunda vez, com cardume monitorado, voltou com 16 toneladas. “Quando esse barco chegou aqui todo mundo abriu o olho.”
O ano era 2015 e o sucesso dos Braga fez explodir o garimpo do atum da pesca de cardume associado na região, que se estende até Areia Branca (RN). Muitos atribuem a técnica a pescadores do Espírito Santo, que notaram a subida dos peixes à superfície
nas boias oceanográficas do limite da ZEE ou das boas desprendidas de plataformas de petróleo. Um artigo publicado em 2007 por pesquisadores da Universidade Federal do Rio Grande já mostrava a experiência de dois barcos com a técnica lá no Sul.
Nenhuma fonte consultada tem certeza, mas uma das teses é a de que o cardume se “associa” à embarcação pelo mesmo motivo que se associa a um dispositivo atrativo, como uma boia. Animais de “sangue quente”, eles habitam a zona mesopelágica (200 m a 300 m de profundidade). Só sobem à superfície atraídos por alimento, por isso a lua cheia (da pesca do espinhel) e as boias, que concentram microorganismos e puxam o resto da cadeia. A chave para dar escala a esta arte é que os mestres descobriram como iludir os cardumes para que se associem à sombra da proa e da popa.
Maraisa Silva Braga não trabalha na empresa, mas é prima de Werly. Todos ali são meio parentes. Filha de um mestre local, ela cresceu na beira do cais. Hoje, com formação superior, entrevista os colegas do pai para saber o volume capturado pelos 240 barcos que desembarcam ali, dos quais 148 são locais. “Em Itarema a pesca sempre foi a principal fonte de renda, mas o atum cresceu muito nos últimos cinco anos.” O trabalho é feito para a Control Ambiental, uma consultoria que presta serviços de monitoramento de impacto ambiental sob encomenda de empresas como a Petrobras
A pesquisa subsidia uma impressionante cifra: segundo a Secretaria de Agricultura, Pesca e Aquicultura do Ceará (Seapa), 62% do atum nacional sai do Estado. Isso equivaleria a algo próximo de 15 mil toneladas. O crescimento é vertiginoso. Do zero em 2014 a 12 mil toneladas de atum em 2017, o número já cresceu 50% em 2018 e de-
veria fechar 2019 com 24 mil toneladas, conforme o diretor de Agronegócio da Agência de Desenvolvimento do Estado do Ceará (Adece), Silvio Carlos Ribeiro, disse ao Diário do Nordeste em janeiro.
Deveria, porque o mercado dá sinais de que não quer tanto peixe. Na data de nossa visita, 26 de fevereiro, a Braga tinha três barcos parados no Porto à espera do sinal verde da indústria de conservas Robinson Crusoe, sediada em São Gonçalo do Amarante (CE) para desembarcar e despachar. A empresa compra 90% do peixe da região. Só Werly fornece 150 toneladas por mês de albacora laje e bonito-listrado. “Hoje o volume se tornou um problema. É uma quantidade de barcos muito grande, muita gente que não tinha nada a ver com a pesca entrou na atividade.”
O potiguar José Holanda Rebouças, conhecido como Zé Nel, é outro termô-


metro do momento atual. Começou em Aracati, teve êxito e converteu barcos lagosteiros de Itarema em atuneiros. Hoje tem 6 embarcações próprias e outras 14 que ele financia com óleo e rancho - comida e suprimentos para a tripulação. O acordo com os armado-


res era receber R$ 0,50 para cada kg de peixe capturado, mas em fevereiro já não era negócio. “Tenho mais de R$ 1 milhão perdido já com isso.” Em 28 de fevereiro, três de seus seis caminhões estavam estacionados na estrada do distrito de Siupé, em frente à planta da Robinson. Nada disso faz Zé Nel mudar seus planos de investimento.“Estou construindo mais quatro barcos. Tenho 11 filhos e, para cada filho, quero deixar um barco.”
Itarema e Aracati, a 40 km dali, são um canteiro de obras náuticas. O volume surpreende, porque cada unidade não custa menos que R$ 500 mil. À beira do Porto, a Braga finaliza a construção de um barco de fibra de vidro - o padrão local é de madeira. A frota própria já soma 16 barcos só para o atum, toda legalizada. Na cidade vizinha, a reportagem avistou mais de 10 barcos em construção em um estaleiro clandestino. Tudo sem licença ou registro no Registro Geral da Atividade Pesqueira (RGP) “Considero que a nossa tendência é aumentar a frota cada vez mais, mas as indústrias aqui precisam se organizar mais para receber este peixe”, avalia Werly.

Estaleiro em Acaraú (CE): ritmo de construção de barcos é muito superior à demanda por pescado
O Poder Público tardou, mas reagiu. A então Seap publicou em 16 de novembro do ano passado a Portaria Interministerial Nº 59-A para definir um limite de até 200 embarcações para as Regiões Norte e Nordeste e 50 embarcações para as Regiões Sudeste e Sul. Critérios e procedimentos ficaram pendentes, assim como a definição dos portos de desembarque obri-
gatório de atuns e afins. Por outro lado, a Seapa criou um curso de capacitação que vai de técnicas de captura ao sistema internacional de classificação de atuns. A primeira turma ocorreu em 26 de novembro. A formação é fundamental, já que muitos ignoram a relação entre a queda do mercado e expansão desenfreada da frota de cardume associado.
Só 10% do produto capturado pela pesca de sombra tem qualidade para sashimi, o que está muito mais associado ao manejo a bordo que à técnica de captura. A Itiban Pescados, que já comprava da região, entrou na captura em 2015 com foco nos clientes da gastronomia oriental. Miguel Shoiti Kikuchi, sócio desta divisão da empresa, foi ao Japão, Taiwan e o sul da Ásia para conhecer técnicas de abate, sangria, armazenagem e até o transporte ao destino final. Aí adaptou o que viu ao Nordeste brasileiro. “Puxamos o peixe a bordo, furamos a cabeça com uma ferramenta para insensibilizar e depois colocamos um cabo na espinha dorsal”, explica. O cabo perfura a medula e imobiliza o peixe, que depois é sangrado, eviscerado, mergulhado em um tambor de água e gelo e acondicionado nas urnas, com uma proporção de 3 kg de gelo para cada kg de peixe.
O encaixe nos restaurantes do Sul e Sudeste é um alento, mas se o ritmo de expansão prosseguir tão intenso a reabertura do mercado europeu é indispensável. A própria Robinson Crusoe é um exemplo disso. Uma das ramificações da filial brasileira do grupo espanhol Jealsa-Rianxeira era despachar atum para a matriz, assim como a Gomes da Costa no sul, mas hoje este fluxo está direcionado ao Equador (3,5 mil toneladas em 2018) e Guatemala (2 mil toneladas em 2018). Em 2017 a Espanha recebeu 4,89 mil toneladas, basicamente bonito listrado.
Carlos Eduardo Vilaça, diretor técnico do Coletivo Nacional da Pesca e Aquicultura (Conepe) e comprador
de lagosta e atum na região, vê um efeito drástico nos preços. De 2012 até dezembro de 2018, o primeiro preço para o bonito-listrado variou entre R$ 3,50 e 4,50. “Com o estrangulamento de destinos alternativos a UE e uma queda no preço internacional, acrescido de câmbio menos favorável e problemas sanitários ocorridos em lotes exportados, a situação se deteriorou muito.” O preço chegou a R$ 2, relata o oceanógrafo. “São situações de evidente abuso econômico, de aproveitamento de situação e de oportunismo.” Nos atuns a situação é similar, com preços entre R$ 5,50 e 6,80.
Apesar do cenário crítico, Vilaça não crê no colapso da atividade e aponta o caminho da regularização. “Fizemos aqui um mutirão de regularização com 14 pessoas cedidas à Seapa. De outubro a dezembro saímos de 28 para 148 licenças de barcos para o atum. Escaneamos todos os processos e colocamos no Serviço Eletrônico de Informação (SEI).” Enquanto isso, Zé Nel, Werly e muitos outros procuram outros mercados para aumentar - ou ao menos conservar - o faturamento da pesca de sombra cearense, estimado em R$ 372 milhões em 2018 com mais de 800 empregos gerados.
Portões fechados: indústria de conservas já não consegue absorver todo o volume e armadores procuram outros destinos, como a culinária oriental das grandes capitais


Uma das fontes consultadas nesta reportagem acompanhava um cliente no Mercado Municipal de São Paulo quando presenciou uma cena curiosa: uma família japonesa reverenciava um atum inteiro exposto na banca, com interjeições de espanto. “Ohhh”, diziam. Provavelmente eles não esperavam encontrar no Brasil um exemplar como aquele da iguaria mais valorizada da culinária japonesa.
A fonte é o engenheiro de pesca Werner Martins e o cliente é a Morota Pescados. “Fiquei impressionado com o respeito que eles demonstraram pelo produto”, conta Martins, um dos observadores de bordo contratados em meados da década de 2000 para acompanhar os barcos estrangeiros arrendados. Curioso, aproximou-se do mestre - o único que arranhava inglês em meio à tripulação chinesa - e perguntou: “Por que furam o peixe?” O

capitão disse que esta era a forma de saber a qualidade da carne daquele animal. Ele só não entendeu como.
Só foi compreender no desembarque, quando conheceu Cesar Calzavara, um médico-veterinário paraibano que aceitou os insistentes convites do tio, Gabriel, para abandonar a clínica e cirurgia de pequenos animais e mexer com atum. “Nunca tinha tido interesse, mas um dia aceitei o convite e me apaixonei.” Observador atento, ele absorveu a técnica de “furar o peixe” com um mestre experiente, Batista, que por sua vez havia aprendido com os norte-americanos.
A análise sensorial é um dos pilares da qualidade do atum, hoje praticada no mundo todo. “É uma sabedoria adquirida com prática”, diz Calzavara, que além de Batista passou pelos Estados Unidos, Espanha e pelos chefs mais exigentes de São Paulo e
Cesar Calzavara (esquerda) é especialista em classificação de atuns, ou fish grader: com uma vara de inox, ele perfura o peixe e extrai uma amostra de carne para classificar o produto e, assim, obter maior valorização

outros Estados. O técnico introduz o sashibu (vara), remove uma pequena porção de carne e avalia cor, frescor, textura, aparência e a interação com a luz. Conforme os indicadores, atribui classificação #1, #2+, #2h, #2, #2-, #3+, #D. A classificação cria faixas de preço muito distintas. “O #1 é mais ou menos três vezes o valor do #3+ para o produtor”, sublinha o especialista. Isso sem falar de gordura. “Se for um atum gordo o #1 dobra de valor.”
A experiência de Calzavara virou tese de mestrado e, mais recentemente, um negócio paralelo às indústrias que o contratam para a análise. Ele notou que havia demanda nacional pelo mesmo produto exportado ao exterior, rastreado desde que sobe a bordo até ser embalado. O cliente consegue saber se chegou vivo a bordo, em que latitude e longitude e até a temperatura do peixe quando pescado. Isso motivou a criação da Fish Tag, uma


Seleção para qualidade tipo exportação faz a alegria dos sushimen, como o alagoano Roger Lima, do Hatsu Izakaya
plataforma comercial que ele inaugurou recentemente em parceria com a prima, Barbara Granek, uma executiva com passagem por multinacionais que vive nos EUA.
A ferramenta se baseia em quatro pilares: marketplace, um canal direto entre compradores e vendedores, sem intermediários; logística, do produtor a porta do restaurante; informações de rastreabilidade; e o pagamento, que poderá ser feito pela internet via aplicativo. “Nosso objetivo é fazer com que essa cadeia seja encurtada, que os produtores possam vender melhor, que os restaurantes possam comprar melhor e os clientes saibam o que estão consumindo”, explica Granek. O atum mostra que a qualidade do pescado, não o volume, pode ser um negócio ainda mais lucrativo. Um big eye de 90 kg classificado no Rio Grande do Norte pode ser vendido no Mercadão de SP acima de R$ 120/kg.
É aí que as histórias de Gabriel e Werner voltam a se cruzar. Fabio Pereira, sócio da paulistana Morota Pescados, estava em busca de um especialista para ajudá-lo a projetar a nova indústria com SIF na capital

paulista. “Ele queria a melhor tecnologia possível para trabalhar com atum”, conta Martins, que depois de navegar com os chineses e aprender com a família Calzavara, fez especialização na indústria com Roberto Imai, na Imai Pesca, em Santos (SP). Quando apresentou este currículo, foi contratado na hora.
A indústria está em fase final de regularização e contou com o projeto e acompanhamento da Adsumus, empresa de consultoria industrial criada por Martins em sociedade com a médica-veterinária Ana Beatriz de Campos Leite. Ambos implantaram nela um aspecto fundamental para garantir a manutenção da qualidade da origem:
o frio. “Esta é a escola asiática. Toda a unidade fabril é atendida por água extremamente gelada. A fábrica de gelo passou por um cálculo fino para atender em abundância o atum.”

A estrutura tem três candle tables, apesar de o SIF exigir apenas um. Na chegada do peixe, o lavador também previsto em lei foi desenvolvido especialmente para a anatomia fusiforme dos atuns. Prateleiras de inox armazenam o peixe de forma similar às gavetas dos navios de espinhel, invenção de Fabio. “Atender à legislação é pouco”, diz Martins. “O atum é mais sensível que uma ação na bolsa de valores. É um pescado para quem sabe o que está fazendo.”



Depois de três anos com safras ruins e capturas de, no máximo, 100 peças por viagem, os mestres das embarcações de espinhel que partem do Rio Grande do Norte já têm motivos para comemorar. Por motivo ainda ignorado, a safra de 2019 já é bem superior. “Cada saída agora traz 250, 280 peixes. Antes não dava nem para pagar o custo”, conta, aliviado, o mestre Araújo, que hoje comanda embarcações de uma das principais empresas da região, a Transmar.
O proprietário da empresa, Alceu Alves Couto, faz um cálculo do mínimo necessário para chegar ao ponto de equilíbrio de cada operação de pesca - que podem superar R$ 400 mil. Só de isca cada barco gasta R$ 30 mil por viagem - a lula importada da Argentina e do Uruguai, é a mais procurada pelos atuns. “Para ter condições de pagar a armação, você precisa ter ao menos 180 peças. Se tiver uma venda boa lá fora, com o câmbio como está, 150 peças é suficiente.”
Para chegar a este ponto, foi necessário investir em tecnologia e formação. É comum ouvir o mestre Araújo falar em termoclina e ressurgência com a familiaridade de um oceanógrafo. Quando começou, há 29 anos, saía para navegar em um mar de incertezas. “Antes era na navegação estimada, como chamávamos. Hoje temos rádio para rastrear as boias e saber onde a linha se rompeu, GPS com carta náutica para navegar, piloto [navegador] com computador de bordo e sonar para encontrar os cardumes.”
Essa busca começa em terra, porém. Braulio Gadión, encarregado da parte operacional da Transmar, fica em contato permanente com o mestre em uma sala contígua no cais próximo à Nortepesca, na Rua Chile. “Verificamos onde estão as demais embarcações, o tráfego, as temperaturas superficiais, altimetria, plâncton, salinidade, temperaturas superficiais e a termoclina do oceano.” Com isso, define as melhores áreas de pesca. Os dados são transmitidos aos mestres diariamente. Gadión também consegue saber a produtividade de cada lance, com informações repassadas pela tripulação.
O clima no mar é hostil, revela o mestre, mas não entre os brasileiros. “Antes havia muito mais peixe próximo à costa, não íamos muito fora da ZEE. Hoje saímos fora e encontramos muito chinês, japonês e espanhois.” Os chineses são maioria, garante. “Eles são muito crueis, o material é mais profundo e se enrola muito com o nosso. ” Se um um barco típico de espinhel do Nordeste situa os anzóis a 100 m, os chineses frequentemente passam de 300 m.
Como os demais concorrentes nacionais, as operações se concentram no período de lua cheia. Se partem todos juntos, todos retornam juntos. O primeiro preço é muito sensível a isso e as empresas com estrutura para armazenar e entregar peixes na entressafra saem na frente. Com o mesmo raciocínio, a Transmar tem um projeto de sair com uma embarcação auxiliar para buscar a produção capturada antes de o pesqueiro retornar. “Assim conseguimos um preço melhor e atendemos clientes que não conseguem segurar o peixe durante o mês inteiro”, justifica Guilherme, o filho de Alceu que coordena a área comercial
Alceu Couto, da Transmar, calcula em 150 peças como o mínimo suficiente para cobrir os custos de uma armação de espinhel para atum
A concorrência é acirrada também em terra, então a empresa procura tratar cada exemplar com esmero para acessar mercados que pagam melhor, como explica Guilherme. “ Em torno de 70% da nossa produção é exportada para os EUA. Disso, 90% é atum e 10% meca.” A Transmar não tem indústria, mas faz a comercialização com apoio da Nortepesca, onde ele é classificado, sifado e embalado. O restante da produção segue em boa parte para São Paulo, mas outras capitais e até o food service local de Natal dispõem destes peixes.
O que faz dele um produto com passe-livre nos principais mercados é o cuidado com a qualidade, do convés à mesa de classificação da indústria. A Transmar foi incorporando alguns detalhes às embarcações que diferenciam o produto. À medida que o espinhel
de 100 km é içado, 6 a 8 peixes sobem a bordo.
“Matamos ele em um tatame [um tapete de EVA] e depois colocamos em um cavalete”, conta o mestre. A estrutura dá conforto à tripulação, que não precisa se agachar para eviscerar o peixe.

Depois o animal segue para um tanque com água a 3 graus negativos.
“Ele passa até 2h ali, até que a temperatura dele chega a 10 graus positivos. Aí tiramos, ensacamos e colocamos na urna.” O “saco” é uma manta que
veste o peixe para evitar a queimadura do gelo. O porão climatizado recebe os troncos, acondicionados lado a lado, mas não sobrepostos.
ção então os recobre com uma camada generosa de gelo fino, para depois acondicionar os próximos peixes, su cessivamente, até encher a urna. Isso em viagem bem-sucedida, claro.




Prepare-se: em breve você poderá comprar e vender atum pelo celular, sem tocar na carteira, sem despesas bancárias e ainda receber antecipado em reais. Duvida? Os sócios da Nortepesca não. Rodrigo Hazin e o irmão Cássio formaram uma subsidiária, Companhia Industrial Atuneira S/A, que nascerá inovadora: irá lançar a primeira criptomoeda relacionada a alguma proteína animal de que se tem notícia no Brasil. É como se fosse uma Quermesse do interior: você troca R$ 10 por uma ficha, que dá direito a um pastel e um caldo de cana. É um passo ousado para resolver um problema simples, mas grave: as diversas mordidas financeiras da compra e venda de peixes.
Na Quermesse do atum, a ficha é a Tuna Coin (TNC), que tem paridade de R$ 1. Suponhamos que um cliente do exterior quer fazer uma compra antecipada de 10 toneladas com desconto. Ele
fecha o negócio em R$ 50 mil, mas com desconto de 10% vai repassar 45 mil TNCs ao fornecedor 20 dias antes da entrega. Toda a transação é feita em segundos por um aplicativo de celular. Aqui no Brasil, o exportador então troca por R$ 45 mil. Como a liquidez é imediata, ele pode antecipar pagamentos a todos os fornecedores.
Toda a hipotética situação descrita acima não teve qualquer participação de uma instituição financeira e, por consequência, nenhuma despesa resultante, como taxas ou comissões. É uma relação de confiança estabelecida entre comprador e fornecedor e, mais ainda, na moeda, como explica Fernando Barrueco, diretor da Bomesp, uma bolsa de moedas virtuais sediada em São Paulo. “É como se fosse um voucher, um contrato fechado entre duas partes com obrigações bem delimitadas: você me paga e eu te entrego atum.” Com o lastro dado por várias transações similares, a TNC pode um dia se tornar um ativo em si mesmo e eliminar a necessidade do Real físico ou eletrônico em algumas transações. Como 60 milhões

de brasileiros não têm conta em banco, a ficha da Quermesse do atum seria uma alternativa para comprar toda e qualquer mercadoria ou serviço.
A Bomesp é a responsável técnica e jurídica do projeto da Companhia Industrial Atuneira. A criptomoeda é só a primeira fase, que envolve ainda um portal de conteúdo (Open Tuna Project) e um aplicativo de rastreabilidade baseado em blockchain. Esta tecnologia vai permitir a coleta e exposição dos dados de captura em um local só, que poderá até subsidiar discussões nos CPGs e no ICCAT. “Com isso acaba a era das anotações no papel de pão”, brinca Barrueco. A informação é distribuída entre vários servidores. Essa descentralização a torna confiável e evita fraudes.
Pode ser um movimento ousado, mas não é inédito. Marcas internacionais do pescado, como a Blue Star Foods, já fizeram um ICO (Initial Coin Offering - como é chamado o lançamento da criptomoeda ao mercado).
“Não estamos inventando a roda”,
assegura Rodrigo Hazin. Segundo ele, a Nortepesca entrará como parceira para contribuir com assessoria e a experiência de 60 anos na pesca industrial. O objetivo é disseminar os meios de pagamento alternativos e expandir as informações de rastreabilidade a todos e, assim, valorizar o atum capturado pelo espinhel brasileiro.
É mais uma ferramenta para evitar o que a família Hazin experimentou com a lagosta - como tudo começou. “[A Nortepesca foi uma] empresa pioneira para industrializar lagosta.” Depois de 20 anos na liderança do segmento, muitos concorrentes chegaram e exauriram os recursos. Diversas indústrias fecharam, mas o mercado ainda pedia produto e os pescadores artesanais começaram a capturar com mergulho, arrasto e outras técnicas insustentáveis. “Nosso receio é acontecer com o atum a mesma coisa. Vai para São Paulo com caminhãozinho de distribuidoras
Fernando Barrueco, da Bomesp: empresa desenvolve moeda digital para transações com atum sob supervisão da Nortepesca
pequenas, não passam nem no Ceasa, não têm licença e garantia de origem. Isso afeta o preço do mercado.”
A procura pela diferenciação é constante entre os Hazin. É por isso que Rodrigo mantém viva a busca de investidores, em parceria com a Norpeixe, de Gabriel Calzavara, para construir uma frota de supercongeladores de atum a -60ºC. Enquanto isso, luta para administrar os reflexos de um passivo trabalhista de embarcações chinesas na Paraíba que colocou a Nortepesca em Recuperação Judicial. “Tìnhamos 500 funcionários, lideramos a pesca de atum, tínhamos um faturamento muito elevado, mas tivemos de assumir um passivo que não era nosso e quase fechamos.”
O plano foi aprovado pelos credores e aos poucos o passivo diminui com a prestação de serviços, comércio e exportação. Com a Companhia Indus-

trial Atuneira, o objetivo é fazer uma integração vertical. “É uma sociedade anônima, queremos agregar produtores e distribuidores ao mercado brasileiro e internacional, em torno de uma marca forte.” Aos 60 anos de idade, os Hazin querem voltar a ter a banca mais disputada da Quermesse.




Atradicional rua Chile, às margens do rio Potengi, tem um pequeno mercado de peixes costeiros que ladeia um muro alto. Do outro lado está o maior porto privado do Nordeste, com 104 metros de comprimento e área útil total de 2.500 m² , onde os barcos descarregam o atum que será transportado por ganchos suspensos em um trilho para dentro da indústria logo à frente. A planta, por sua vez, tem 5.000 m2 e capacidade instalada para processar 100 toneladas/dia e estocar 80 toneladas/dia em quatro túneis. A área de estocagem, em expansão, vai sair de 1.200 toneladas para 2.000 toneladas.
Todo este complexo pertence à Produmar e foi construído ao longo de quase 50 anos pela família do fundador, Arimar França, já falecido. Arimar Filho e a irmã, Rayana, estão à frente do negócio de múltiplas ramificações. “São onze pequenas operações, como barcos próprios, exportações, importação de lula, importação e venda de material de pesca, prestação de serviços, fornecimento de gelo, armazenamento, logística e comercialização”, descreve Arimar. Uma peixaria situada em um casarão colonial também na Rua Chile oferece uma amostra do amplo portfólio.
Mas o principal negócio atual é a venda externa, que corresponde a mais de 70% do faturamento. O fechamento da União Europeia ao pescado nacional foi um golpe severo, mas bem administrado. “A Europa era 15% do faturamento do nosso [produto de] alto valor agregado, mas do resultado era quase 35%.” Ainda assim, Arimar garante que a empresa conseguiu crescer 30%. “Temos uma descentralização muito grande, trabalhamos com lagosta, camarão, diversos peixes costeiros.”




À esquerda, funcionário retira mantas acondicionadas a bordo para proteger o peixe. À direita, Arimar Filho considera que o mercado vai regular a demanda por atum de sombra ou de espinhel, mas ambos têm qualidade
Nos 10 últimos anos do negócio, o empresário viu a Produmar ficar 16 vezes maior com essa versatilidade e a queda de alguns concorrentes. Para manter o ritmo ele aposta muitas fichas no mercado interno com um produto ainda inexplorado: o lombo de atum. “Estamos importando uma máquina de limpeza dos EUA para aumentar o shelf-life e conseguir vender o lombo fresco em caixa de isopor para restaurantes e distribuidores de todo o Brasil.”
Ele esteve recentemente no interior paulista e viu grande demanda pelo produto processado no Rio Grande do Norte. “Vamos fazer o lombo de exportação, mas também em outras classificações. Posso também fazer um lombo para o restaurante fazer na chapa, não precisa ser top de linha desde que tenha frescor.” Para isso, ele conta tanto com 7 barcos próprios e outros 5 de espinhel, quanto com os de sombra, parte da frota de outras 25 embarcações que descarregam ali.
É por isso que ele não engrossa o coro contra a modalidade praticada no Ceará e em Areia Branca (RN). “Eu recebo os dois peixes e conheço bem, o peixe de sombra é similar se trabalhado corretamente. Só eu falo isso por aqui.” Quem vai fazer a distinção entre um produto e outro serão os diferentes nichos de mercado. “Você pode ter o melhor peixe do mundo, mas a melhor classificação que existe ainda é o mercado.”

A oferta de peixes, crustáceos e moluscos
Há 45 anos no mercado, a Noronha Pescados vai para a segunda etapa dos lançamentos para a temporada 2018/2019. Primeiro foi o bloco de polaca do Alaska single-frozen, agora é a vez do filé de salmão chileno em porções de 125g com embalagem individual. As porções menores são indicados ao consumo diário de quem mora sozinho.


A Opergel Alimentos, responsável pela marca Oceani, segue na ampliação da linha com o que considera o “bacalhau certo” para a Quaresma: lombo de bacalhau de 600g e 1kg e o bolinho de bacalhau de 300g.

Tudo feito com o nobre Gadus morhua, ou bacalhau do Porto.

A típica farinha para empanar pescado da culinária oriental tem mais uma opção de fornecedor. Com uma das maiores capacidades de moagem de trigo do Sul do País, a Orquídea, de Caxias do Sul (RS), entra com foco em peixes e frutos do mar com a panko, mais flocada, adequada para a crocância destas frituras.

A Copacol procura levar aos nativos a hegemonia já conquistada com a tilápia. A Linha Rio tem produtos congelados em pacotes de 800g, em posta ou filé de pintado com pele, costelinha palito ou



costela de tambaqui ventrecha, filé de tambaqui com pele e posta ou filé de pirarucu.




A Swift se diz “cada vez mais preocupada em honrar o compromisso com a natureza” e por isso traz ao Brasil a primeira linha de salmão chileno com certificação de sustentabilidade. O produto da Cermaq provém de fazendas certificadas com o selo da Aquaculture Ste wardship Council (ASC) na região de Punta Arenas, no Chile. Entre as novidades com o selo estão o lombo de salmão premium de 650g e o filé de salmão premium com 900g.



Com nova roupagem desde a troca de logotipo em 2018, os filés de tilápia Brazilian Fish também receberam embalagem reformulada. Outra novidade da empresa é o bolinho de peixe com mandioca e especiarias de 258g, para servir como aperitivo e no acompanhamento de refeições, nas versões com e sem recheio de catupiry.





Escassez hídrica, maior proximidade dos centros consumidores e busca por maior rentabilidade leva produtores a diversificar sistemas de produção, mas viabilidade ainda preocupa
Aaquicultura mundial está em trânsito. Não apenas em busca de aspectos produtivos mais eficientes, mas de uma mudança de paradigma: produzir mais, com menor custo, em menor tempo, próximo aos mercados e com a menor quantidade de água possível - de preferência repondo só o que se perde com a evaporação. Outro fator fundamental é a pressão social sobre os cultivos mais visados por conta de seus impactos ao entorno, como a salmonicultura e a carcinicultura.
Não é casual, portanto, que uma salmoneira norueguesa tenha anunciado recentemente planos
para duas fazendas de salmão em recirculação (RAS) nos Estados Unidos. A Nordic Aquafarms tem um projeto para uma cidade no lagosteiro Estado do Maine para um volume anual de 30 mil toneladas e um aporte superior a US$ 500 milhões. Outro projeto, recém anunciado, injetará US$ 400 milhões em Eureka, na ensolarada Califórnia, para produzir 22,6 mil toneladas de peixe por ano com um corpo de 80 funcionários.
A Nordic não está sozinha. De olho no maior mercado de consumo de pescado do mundo, diversas empresas especializadas em RAS também traçaram planos para se estabelecerem nos EUA depois de experiências bem-
sucedidas na Europa e Ásia. Só a Pure Salmon, companhia especializada em RAS apoiada por um fundo de investimento pretende chegar a 260 mil toneladas de salmão Atlântico até 2025 com unidades no Japão, China, França, Itália e também em solo norteamericano. Uma unidade na Polônia, já está produzindo 580 toneladas.
Quem desenhou esta planta é a israelense AquaMaof, referência mundial em RAS que tem planos ambiciosos também para o Brasil. “Sonhamos em elaborar um projeto de cultivo de salmão nos arredores de São Paulo”, conta Rodrigo Capó Viera, representante da empresa para


a América do Sul. A companhia esteve na última AquaSur, em Puerto Montt (Chile), onde fez contato com brasileiros interessados em sistemas do gênero.
Embora tenha maior disponibilidade de água que todas as demais potências aquícolas globais, o Brasil também sofre com escassez hídrica. Períodos de estiagem cada vez mais longos, crescimento de centros urbanos,
distância dos polos produtores às indústrias e ao consumidor, margens reduzidas, insumos nutricionais com muita oscilação e questões normativas. Tudo isso faz com que os produtores considerem cada vez mais a possibilidade de investir em RAS e sistemas alternativos aos viveiros escavados e tanques-rede em reservatórios.
Por conta de restrições de doenças e necessidade de maior controle, as fases de cultivo indoor tem sido cada vez mais prolongadas em todo o mundo, inclusive no país, segundo avalia Marcelo Shei, diretor da Altamar. “Se formos considerar que boa parte dos alevinos de tilápia produzidos no Brasil foram incubados em algum tipo de sistema fechado, podemos imaginar que a expansão para as outras fases é só uma questão de oportunidade.”
Ele considera que tais sistemas ficarão mais viáveis com o aumento de restrições de produção, seja por custo de área, aumento das exigências ambientais, controle sanitário ou outras restrições aos métodos atuais.
É por isso que assistimos, nos últimos anos, a uma profusão de cursos e experimentos com intensificação, bioflocos, recirculação de água, sistemas multitróficos, nutrição complementar e outras experiências. De Norte a Sul, ainda são poucas as grandes empresas dedicadas a assumir os investimentos e riscos inerentes às novas tecnologias. A Geneseas e seu projeto de juvenis de tilápia em bioflocos em Santa Fé do Sul (SP)



(como publicado na Seafood Brasil #24), o cultivo consorciado de camarão vannamei e tilápia e os projetos intensivos de camarão do Nordeste ao Sul são exceções.
O engenheiro de pesca Enox de Paiva Maia foi um dos pioneiros a colocar em escala um projeto alternativo aos sistemas extensivos de carcinicultura em voga em meados de 2000. Na época, a Aquarium, de Mossoró (RN), sofreu os efeitos da Síndrome da Necrose
Idiopática Muscular (NIM) como todos os vizinhos da região. Os animais não passavam de 10g, tamanho exigido pelo mercado à época.
Para manter a atividade produtiva, era preciso prosseguir. Baseado em pesquisas que havia feito na Universidade Federal de Pernambuco (UFPE) na década de 80, Maia resolveu transformar parte da fazenda em uma área experimental para testar o policultivo de vannamei e tilápia. A
Jenner Menezes, da Biofish: experimento de produção integrada de nativos com espinafre d’água reduziu custo de produção em R$ 1,00/kg
tese era a de que o peixe teria um efeito positivo sobre o convívio com a doença no sistema.
“Tudo indica que a tilápia produz uma espécie de probiótico que contém o surto da Nim. Ainda hoje é a mesma coisa com a mancha branca”, diz o empresário. A tese se mostrou acertada e o experimento cresceu: dos 5 hectares iniciais, hoje são 25 hectares. Para cada 70 toneladas de camarões, a fazenda engorda 30 toneladas de peixe. “A cada ciclo produtivo da tilápia, fazemos 3 ou até 4 ciclos de camarão”, conta Maia.
A produção poderia crescer 20 vezes mais, caso houvesse demanda de mercado pela tilápia de água salgada - há casos de crescimento contínuo em salinidades de até 30 ppm. Só que o custo de produção da engorda consorciada é mais alto, o que atrapalha os planos de expansão. “No camarão, gasta-se R$ 8 mil em um viveiro de 1.000 hectares com densidade de 10 camarões de m2; com policultivo o investimento triplica.” O capital de giro precisa ser então de 3 a 4 vezes maior que o monocultivo, mas Maia adverte que a rentabilidade também pode triplicar. Ele relata ainda experiências promissoras com o panga: 16 toneladas do peixe e 1500 kg de camarão/hectare no mesmo viveiro.
A integração de espécies aquáticas tem múltiplas funções (Veja box). A questão sanitária é uma das principais e, em um sistema hiperintensivo com bioflocos como o da Camanor, ela é ainda mais relevante. Na Fazenda Cana Brava, em Canguaretama (RN), as densidades de camarão ultrapassam 400 camarões/m2 em alguns viveiros com temperatura controlada por estufas personalizadas.
Para a professora Patricia Valenti, a aquicultura multitrófica será fundamental tanto para subsistência quanto para fins comerciais

Os investimentos são altos e os fornecedores precisam acompanhar a dinâmica constante de novos testes e implementações. “Cada dia de viveiro parado em construção custa muito para uma empresa deste porte”, indica José Carlos Di Salvo, diretor da fabricante de estufas Plantfort. A empresa forneceu algumas unidades a pedido da Camanor para comparar com estruturas fornecidas pela Zanatta. Ambas foram personalizadas, com janelas basculantes para melhorar o controle de temperatura. Agora a Camanor investe na automatização destas janelas, que se abrem ou fecham
conforme a indicação de temperatura captada por um sensor.
As tilápias são produzidas separadamente em densidades de 4 kg/m2, mas a água é a mesma que circula nos viveiros. O peixe dá estabilidade a esta água, controla o nível de bioflocos - que se tornam parte da dieta -, e os compostos nitrogenados. “[A tilápia] nunca deixará de ter esse papel de operária, mas já é um produto Camanor”, avalia o supervisor do núcleo de peixes marinhos, Ronaldo Barradas. Ele coordena diversos experimentos com peixes na fazenda, entre os quais a




produção de alevinos, que já apuram sobrevivência média de 80%.
São as formas jovens do próprio camarão, no entanto, que recebem a atenção principal da empresa no momento. “Estamos buscando cada dia mais eficiência produtiva para baixar os custos de produção e conseguir ser competitivos no mercado interno e no externo”, diz Luiz Peregrino, diretor técnico. O início da operação do laboratório próprio de produção de pós-larvas, em Canguaretama (RN), é uma destas medidas, segundo ele. “Nosso primeiro povoamento na fazenda com nossas PLs foi em 28/02 e, em março, já ficamos totalmente independentes do mercado, produzindo 100% da nossa demanda.”
A estimativa é produzir de 20 a 30 milhões de PLs/mês na fase inicial.
Adubo peixeiro
A aquaponia é a expressão mais popular da aquicultura multitrófica, quando ocorre o cultivo de espécies diferentes com nichos tróficos complementares, conforme explica a professora do Caunesp e Unisa Patrícia Valenti. “Esse sistema imita o que ocorre na natureza, é muito eficiente sob o ponto de vista de espaço, água, energia e nutrientes. É o sistema mais incentivado de aquicultura na Europa atualmente.”
Sistemas multitróficos são utilizados há milhares de anos. Até hoje oferecem subsistência para populações na Índia, China e Bangladesh, como lembra a professora. “Podemos citar os cultivos envolvendo peixes e camarões em campos de arroz; os cultivos integrando agricultura nos taludes de viveiros
Rafael Barone, da Partnerfish: RAS é um sistema promissor para o Brasil, principalmente para espécies de maior valor
contendo peixes e camarões de água doce na Ásia.” Estes últimos, conhecidos como GHER, são uma estratégia de desenvolvimento agrícola e segurança alimentar. Ela acredita que a participação dos sistemas multitróficos, principalmente a aquaponia, deverá aumentar significativamente nos próximos anos.
Se no policultivo a tilápia é operária, na aquaponia são as hortaliças, frutas e legumes que trabalham em prol da espécie animal. Basicamente, elas sequestram da água os compostos nitrogenados e absorvem o excesso de nutrientes, melhorando a qualidade da água. Esta é a linha de trabalho que a AquaMaof procura imprimir a seus projetos indoor de aquaponia integrada em grande escala. “As plantas de cultivo de peixes de AquaMaof são rentáveis, mas a incorporação da aquaponia torna ainda mais atrativo o sistema, já que se alivia o fluxo de caixa”, avalia Capó.
A empresa assessorou a Rybia Farma, uma aquaponia eslovaca, a instalar o sistema de cultivo de clarias (bagre africano) em sistema de recirculação de água integrado com tomates. Ativa desde setembro de 2015, a planta compra alevinos da Holanda e os engorda em densidades de 330 kg/ m2 até que cheguem a 1,5kg em seis meses. “A produção anual é de 1.000 toneladas de peixes para 350 toneladas de tomate”, informa Capó.
A mesma dinâmica orienta o uso de plantas aquáticas, um caminho já testado no Brasil com bons resultados, como mostra a experiência do consultor Manuel Braz. Chamado pelo Sebrae do Espírito Santo, ele recebeu o desafio de melhorar a conversão alimentar de 43 produtores locais. Decidiu introduzir


Sistemas e tecnologias de cultivo*
Sistemas em que a alimentação de uma das espécies com resíduos, nutrientes e também por subprodutos gerados por outra espécie presente no mesmo ambiente. Esses subprodutos são reciclados para se transformarem em insumos para demais espécies. Diminuem custo de produção e oferecem renda mesmo em períodos pós-despesca da espécie principal.





Usa nutrientes contidos na biomassa microbiana e diminui o custo de ração. Gera grande produtividade com altas densidades, mas também requer altos investimentos iniciais, mão de obra bastante qualificada e alto gasto de energia. O sistema se torna uma comunidade, com algas, zooplâncton, microrganismos etc. Com diversas espécies, qualquer mudança na qualidade de água e temperatura leva-se um tempo para estabilizar a população.


Efluentes são reciclados e devolvidos para os mesmos viveiros. Integram o conceito de “Economia Circular” e têm um futuro bastante importante devido à economia de água e redução dos impactos ambientais. Pode ser instalado em plenos centros urbanos em ambientes indoor com sistemas de filtros biológicos. São muito caros, pelo custo energético, e normalmente usados no Brasil para larviculturas. Espécies mais valorizadas, como o salmão, compensam o investimento.


Modalidade de sistema multitrófico adequado para cidades e área rural. Boa alternativa para reduzir emissão de efluentes, entretanto deve ser dimensionada de forma a priorizar a produção principal: peixes ou vegetais. Se a quantidade de um dos dois atores do sistema muda bruscamente, ocorre desequilíbrio.

a lemna, ou lentilha d’água, com a função de reduzir os custos de ração. De cara, já teve um problema. “Esta planta é muito palatável, então tivemos vários casos de ataque das lemnas por pato selvagem, galinha, porco, gado etc.”
A vantagem é que ela também cai no gosto dos peixes. Uma das fazendas em que Braz implantou o sistema tinha três viveiros com 1.500 m2 cada, mas muita escassez de água, o que atrapalhava a reposição e a limpeza dos dejetos. “Então usamos dois viveiros para engorda e um viveiro como um filtro”, explica. “A água dos dois viveiros acima desciam para o terceiro, onde produzimos lemna. Quando havia problema de água, eu bombeava água do viveiro com a planta, que se nutria dos dejetos dos outros viveiros.”
O consumo de ração seguia a proporção de 1,5 tonelada para 1 tonelada de peixe. Braz passou a dar só metade da nutrição adequada para complementar com lemna. No final da
Exija do seu fornecedor a qualidade dos produtos Natubrás


Matéria-prima da melhor procedência, ótimas práticas de fabricação, instalações que respeitam a legislação e equipamentos de congelamento ultrarrápido são alguns dos fatores que garantem o padrão de qualidade Natubrás São camarões, lulas, mexilhões, polvos e cortes nobres de peixes, em embalagens práticas e seguras ao consumidor.




engorda, o custo de produção de R$ 3,50/kg caiu R$ 1,00/kg. “A economia para aquele produtor foi de R$ 6 mil a R$ 7 mil.” Um experimento similar foi aplicado em Rondônia, em parceria com a Biofish, e a redução do custo de produção foi o mesmo, embora a planta utilizada tenha sido o espinafre d’água.
A água adubada pelo peixe é uma grande ferramenta para redução de custos e até de pesticidas, porém é preciso escolher se o foco será nos peixes ou nos vegetais. “Quando se dimensiona a produção de aquaponia
normalmente você é um produtor de hortaliças, não peixes. Muitas vezes nestes sistemas você nem tira o peixe ou desequilibra o sistema”, avalia Rafael Barone, consultor da Partnerfish. Há também uma questão de eficiência energética, explica. “Se fará uma ração para alimentar o peixe e ele fornecerá o resíduo para servir de adubo às plantas, é preciso produzir soja e milho. Você perde eficiência na alimentação dos peixes e transforma isso em fezes. No final das contas você está transformando soja em hortaliças.”
Sem alimento introduzido
Se alguns buscam suavizar o custo com a nutrição, outros são ainda mais radicais e removem completamente a introdução de rações e vegetais.
A Primar Orgânica, sediada em Tibau do Sul (RN), é uma fazenda que cultiva camarões e ostras em viveiros escavados com densidade de 4 camarões/m3, baixa densidade, sem aeração e sem arraçoamento. “[Os animais vivem da] alimentação natural que existe no fundo do viveiro”, conta a diretora, Márcia Kafensztok.
A Primar fechou 2018 com a produção de 36 toneladas de camarão e em torno de 36 mil ostras. O volume produzido é propositalmente baixo, mas deve crescer com a adoção de um sistema bifásico: berçários intermediários para depois levar os animais à engorda. “A produção orgânica tem baixa produtividade, se compararmos produção de kg/ ha com outras fazendas de cultivo convencional. A introdução de demais organismos para cultivo, como as ostras, é um recurso para aumentar a biomassa dentro dos viveiros”, indica a empresária.
A introdução de tainha nos viveiros de ostras e macroalgas nos cultivos de camarão também dá mais equilíbrio ao sistema, que funciona de forma muito parecida ao que ocorre no estuário. A ausência da aplicação de produtos químicos, pesticidas, transgênicos, antibióticos e hormônios credencia a produção como orgânica, entretanto o mercado ainda não valoriza esta condição. “Nas vendas, a agregação de valor pelo produto ser orgânico não acontece. A Primar produz de forma orgânica, mas o processamento não está certificado como orgânico.” Desde o ano passado, a empresa processa parte da produção na Costa Azul Camarões, que tem registro no Serviço de Inspeção Federal (SIF). O selo nas embalagens de 1kg ajuda a vender a outros Estados, embora não como camarão orgânico.



PeixeBR apura crescimento de 4,5% na piscicultura nacional sustentada por forte expansão da tilápia; nativos caem e panga passa a ser monitorado
Texto: Fabi Fonseca | Edição: Ricardo Torres
Aanálise sobre os dados gerais do Anuário 2019 da Associação Brasileira da Piscicultura (PeixeBR) coloca dois pontos sob os holofotes: o aumento de 4,5% na produção geral, para 722,5 mil toneladas, e a expansão da tilápia, que rompeu a barreira das 400 mil toneladas e consolidou o Brasil no quarto lugar mundial entre os produtores da espécie. O presidente-executivo da associação, Francisco Medeiros, apresentou os números em evento no fim de fevereiro, em São Paulo.
O resultado não foi melhor por conta de um combo de fatores, segundo a PeixeBR. Lentidão nos processos de regulamentação nos Estados, greve dos caminhoneiros, problemas sanitários, mercadológicos e climáticos influenciaram no desempenho. As espécies nativas mostraram o pior performance, com decréscimo de 4,7% sobre o ano anterior em Rondônia, Roraima, Pará, Maranhão e Mato Grosso, os maiores produtores.
Com os nativos em segundo plano, a tilápia foi o eixo central do Anuário 2019. Se em 2017 ela representava 51,7% da produção total de peixes de cultivo, com 357.639 toneladas, em 2018 passou para 55,4%, com 400.280 toneladas. O salto foi de 11,9%, consolidando o País na 4ª posição mundial de produção da espécie, atrás de China, Indonésia e Egito.
Na análise dos Estados que mais despescaram em 2018, nenhuma surpresa. Paraná segue na liderança folgada, com ascensão de 16%, para 129 mil toneladas. São Paulo vem na sequência, com 73,2 mil toneladas, enquanto Rondônia diminuiu 5,5% - mesmo assim conservando o terceiro lugar.
PR na dianteira
O polo paranaense saltou de 112.000 toneladas para 129.900 toneladas em 2018, de acordo com a PeixeBR, que avalia o desempenho como reflexo dos consistentes investimentos realizados nos últimos anos, sobretudo pelas cooperativas locais. São Paulo também foi destaque no período com 73.200 toneladas produzidas. Com o crescimento de 5,3%, assumiu a segunda colocação do ranking.
Já Rondônia caiu 5,5% e ficou na terceira posição com 72.800 toneladas no geral, mas com uma produção totalmente focada em nativos se mantém como a líder no segmento. Mato Grosso caiu 12,08% e fechou o ano passado com 54.510 toneladas no quarto lugar. Logo atrás vem Santa Catarina com 45.700 toneladas.
Na sétima colocação, Minas Gerais cresceu 14,3% com 33.150 toneladas produzidas e se manteve na mesma colocação de 2017. Entre os destaques negativos do Anuário 2019, Goiás caiu duas posições e ficou com a oitava colocação com 30.630 toneladas, uma queda de 7% em relação ao ano retrasado, quando contabilizou 33.000 toneladas.
A Bahia ficou com o penúltimo lugar do top 10 com 30.460 toneladas em 2018 contra 27.500 do ano anterior. E o Mato Grosso do Sul foi a novidade da lista ao atingir 25.850 toneladas produzidas em 2018.
Nos casos de Mato Grosso e Rondônia, Medeiros atribui a queda a uma redução da reposição de estoques nos viveiros em 2018, em razão de um fraco desempenho de vendas em 2017. “Hoje a gente tem uma menor quantidade de peixes porque o mercado do ano anterior foi ruim, os produtores colocaram menos alevinos”, disse.
Já o Maranhão teve desempenho surpreendente, com evolução de 47,4% para a sexta posição total ao atingir 39.050 toneladas, das quais 35.200 toneladas são de nativos; no ano de 2017, o total produzido havia sido de 26.500 toneladas. O Estado também é o maior produtor nacional de panga.
O Pará cresceu 18,6% com 23.720 toneladas que deixaram o Estado na 11ª colocação, ele também está entre os líderes na produção de peixes nativos. Fechando o ano de 2018 bem na atividade, Pernambuco cresceu 38% ao produzir 23.470 toneladas. E o Rio Grande do Sul também encerrou o ano passado com um saldo positivo, teve 23.000 toneladas produzidas, que correspondem a um salto de 4,5%.

A autorização para a criação do panga em alguns locais no ano de 2018 também é vista como fator positivo pela PeixeBR. A entidade ainda não tem os dados relativos ao cultivo da espécie, mas a PangaBR, associação que reúne os produtores, estima que o Brasil produza hoje em torno de 700 toneladas do peixe em São Paulo, Maranhão e Rio Grande do Norte.



Tilápia
400.280
Nativos
(Tambaqui, pintado, pirarucu e híbridos)
287.910
Carpas, trutas e panga
34.370
Tilápia

Tilápia na boca do povo
Nativos (Tambaqui, pintado, pirarucu e híbridos

Carpas, trutas e panga

Conforme a PeixeBR, o Censo Agropecuário IBGE 2017 mostrou que a tilápia está presente em quase todos os Estados brasileiros, embora em alguns –especialmente do Norte – não haja comercialização. Outro fator considerado importante neste ano pela entidade foi a liberação para a produção da espécie em tanques-rede no Tocantins e Mato Grosso.
Entre os peixes nativos, o levantamento aponta a liderança do tambaqui no segmento, que também estaria presente em quase todo o País, com exceção do Ceará e Distrito Federal. Apesar disso, no ano passado a produção de peixes nativos foi 4,76% inferior a do ano anterior, com 287.910 toneladas. O segmento passou a representar 39,84% da produção total, que em 2017 era de 43,7%.
No grupo “outras espécies”, a carpa responde por mais de 80% das 34.370 toneladas produzidas em 2018, um salto de 8% sobre 31.825 toneladas de 2017. A categoria, que também inclui a truta, participou com 4,6% da produção total de peixes de cultivo do ano passado. Essas espécies estariam presentes em 19 Estados de todas as regiões do País. Rio Grande do Sul, Santa Catarina, Paraná, Minas Gerais e Espírito Santo são os cinco maiores produtores e, juntos, representam 94,4%.


Apesar de alta procura por pescado e frutos do mar na Semana Santa, poucos restaurantes se empolgam na produção e preparação especial para a data
Texto: Fabi Fonseca | Edição: Ricardo Torres

Entre o tradicional peixe da Sexta-Feira Santa e o bem embrulhado ovo de páscoa do domingo, a Quaresma chega ao fim com aumentos de consumo de pescado no Brasil. No período da Quarta-Feira de Cinzas à Sexta da Paixão, a tradição extrapolou a fé cristã e estabeleceu o hábito alimentar do consumo de carnes brancas, em especial os peixes.
Ao que parece, no entanto, o food service ainda não explora totalmente o potencial do período. A Seafood Brasil perguntou em fevereiro a diversos restaurantes de todo o país como estava a preparação deles para a Semana Santa. Entre as poucas respostas que chegaram, o Santo Dica, gastrobar do bairro de Pinheiros, em São Paulo, por exemplo, reconheceu não haver uma organização própria para a Semana.
“Não há nenhuma grande alteração especial nesta data, só incluímos mais opções de peixes; os pratos com bolinho de bacalhau e salmão já saem o ano todo, assim como o bacalhau das sextas-feiras”, disse Cristiane Souza, responsável pelo marketing corporativo da empresa.
Uma lula recheada também entra no cardápio do período, que tem ainda
isca de tilápia e salmão com shimeji. “O salmão com shimeji e molho agridoce vem com purê, arroz ou legumes de acompanhamento e é o carro chefe do pescado”, declarou. Outro êxito do estabelecimento é o hambúrguer de salmão com receita da casa. Ainda que não faça nenhuma campanha, a procura por peixes na loja costuma aumentar consideravelmente: “A saída de pescado aumenta 60% nesta época e acaba superando a de carne.”
A casa de culinária japonesa Sushi Show pertence ao mesmo sócio-proprietário do Santo Dica, Adriano Trindade, e opera com rodízios e à la carte. A busca por pescado no local também cresce bastante nesta época. O restaurante oferece serviço delivery, enquanto no Santo Dica as encomendas só são entregues se os pedidos forem da região.




Na churrascaria Gramado Grill Raposo da Família Bazi, na Granja Viana, em Cotia (SP), também não há grandes adaptações. O estabelecimento costuma revezar os dias da semana entre o linguado, merluza, anchova negra, salmão, pescada amarela e o bacalhau, mas para a Sexta Santa há poucas diferenças. “A programação é a mesma na Semana Santa, exceto na sexta-feira, em que servimos todos os tipos de peixes e acrescentamos a sardinha, salada de
bacalhau e a maionese de salmão”, comentou o gerente da casa, Sedenir Milan.
Para o gerente mesmo a carne vermelha sendo a predileta do público local, o pescado também vem com uma boa procura nos dias comuns, na Semana Santa do ano passado foi perceptível o aumento da preferência por peixes. “Lembro que na sexta- feira Santa de 2018 a diferença nos pedidos foi cerca de 20% a 25% a mais do que nos outros dias”, declarou.

Prato de tilápia do Pé de Peixe, em Botucatu: diversificar o cardápio é um dos caminhos para expandir as vendas
Fora da capital brasileira da gastronomia já há mais interesse na data. Em São José dos Campos, a casa especializada em pescado e frutos do mar Empório, Peixes e Companhia, da chef Thais Okamoto, oferece desde 2008 uma grande variedade de pratos todos os dias. “A Semana Santa é o nosso Natal, nesta data as vendas aumentam 100% no consumo local e também no delivery e nas encomendas”, declarou.
É por isso que a preparação do ambiente ganha uma temática própria: a chef costuma montar a mesa de display e enfeitar com ovos de páscoa, coelhos de pelúcia passam a fazer parte da decoração especial e dividem o espaço com alguns livros culinários sobre bacalhau. No cardápio, no entanto, poucas mudanças. Os tipos de bacalhau salgado e dessalgado dividem a grande procura com o camarão, pescada amarela, abadejo, lula, polvo e mexilhão.
Okamoto aproveita a data para acrescentar o bacalhau à portuguesa,




Calderon* dá dicas rápidas para marketing de restaurantes na Semana Santa
Milhões de cristãos entraram em período de Quaresma na Quarta-feira de Cinzas e isso significa que muitos evitarão carne vermelha até o dia da Páscoa. Então, o que os donos de restaurantes podem fazer enquanto uma parcela de seus clientes não consome carne vermelha?
Um cartão anexo ao cardápio e um display de mesa
Isso já basta para apenas destacar quais são os pratos com pescado.
Redes sociais são essenciais
Para realmente ganhar novos clientes as redes sociais são primordiais. Faça uma campanha mostrando que está atento a este cliente e quais os pratos disponíveis com fotos bem tiradas e “apetitosas”. Capriche também nas legendas aproveitando para contar um pouco da história da celebração. Impulsione geograficamente este post, para apenas clientes da sua região.
E-mail marketing “Você sabia?”
Enviar um e-mail marketing para sua lista de contatos também é muito importante. Eles já te conhecem, mas sabem que tem pescado no seu cardápio?

Com esta campanha, além de novos clientes você mostrará o quanto seu restaurante é inclusivo atraindo também a simpatia do público.
*Márcia Calderon é formada em propaganda e especialista em marketing, criadora do Portal Restaurante de Sucesso e um canal no You Tube. Além de produzir matérias também faz consultoria, oferece cursos onlines e presenciais e dicas de marketing para restaurantes.
bacalhau à Gomes de Sá, bacalhau espiritual e salada de bacalhau. A espécie é uma das especialidades da chef, que coordena e apresenta um curso sobre bacalhau no projeto Cozinhar e além dos cursos o programa inclui treinamentos, aulas de cozinha, workshops e consultorias para diferentes cozinhas.
A Cuesta do Vale do Aracatu é um ponto turístico famoso de Botucatu (SP), onde há um ano funciona o restaurante
de Paola e André Camargo, diretores da Escama Forte - tradicional fornecedora de insumos e equipamentos para aquicultura. O Pé de Peixe, no entanto, é especializado em todo tipo de pescado, oriundo de cultivo ou da pesca. O tambaqui, camarão e a tilápia lideram a preferência do público - a espécie em iscas também é unanimidade entre as porções. Lambarizinho no fubá frito, pasteizinhos variados e até ostras frescas e gratinadas, mariscos e camarões na brasa compõem as opções rápidas.

Decoração é essencial para expandir a experiência da data comemorativa

Na Semana Santa, a procura sobe quase 50%, segundo indica a proprietária. Alterações no cardápio só ocorrem na dependência de surgimento ou escassez de alguma espécie. A feijoada de frutos do mar, com feijão branco, peixes, camarões e mexilhões, acompanhada de arroz branco e farofa de banana da terra com bacon está entre os pratos preferidos da época. O risoto de camarão e a tilápia desossada grelhada também são campeões no menu santo.
O que muda mesmo é na equipe, que recebe reforço na cozinha e no salão. “Contrato pelo menos mais duas pessoas para cozinhar e outra para suporte na lavagem dos pratos e limpeza. Já no salão, normalmente no final de semana trabalhamos com dez garçons e contrato mais dois ou três”, conclui.


Anderson Oliveira concilia função no tradicional Spot para fazer sua peixaria dar certo
Texto e Fotos: Fabi Fonseca | Edição: Ricardo Torres
Anderson Oliveira dedicou 16 dos seus 35 anos ao Spot, onde começou como office boy até chegar a coordenador de compras. A rede tem uma loja em um tradicionalíssimo ponto bem próximo à Avenida Paulista e outra no Shopping JK, na Vila Olímpia, ambas regiões nobres de São Paulo. Mas é a cerca de 20 km dali, no município de Taboão da Serra (SP), onde Oliveira resolveu estabelecer sua peixaria.
Acostumado com a pesquisa de origem e qualidade dos alimentos, ele ingressou no universo do pescado e colecionou grandes amizades com peixeiros e clientes. Um deles comentou que um conhecido queria vender uma peixaria em dificuldades. Durante um mês se sentou na calçada do supermercado situado do outro lado da avenida para avaliar o comércio: “O lugar era arrumado, porém o cheiro de peixe era tão forte que dobrava a esquina. Ali eu vi o tamanho do desafio que iria enfrentar.”


Para alguém que “não conhecia nem uma sardinha direito”, tinha a missão de fazer o investimento dar certo. A parte difícil foi “falar a mesma língua” no negócio com os fornecedores e pescadores, ele reconhece: “O dia-a-dia era acordar 1h da manhã, calçar as botas e por a mão na massa, ou melhor no gelo: aprender a diferenciar os produtos, negociar valores e fazer a estocagem.”
A peixaria Oliveira hoje funciona de segunda a sábado, das 8h às 20h, o que exigiu a participação da esposa de Oliveira, Ana Paula, e mais sete funcionários. São eles que cuidam diariamente da loja, já que ele não deixou o Spot. Além da venda, o negócio também é uma transportadora de pescado capaz de abastecer cerca de 20 a 30 restaurantes. Junto à câmara frigorífica que construiu com capacidade de estocar 30 toneladas de pescado, também fabrica cerca de três toneladas de gelo para uso próprio e até de outras peixarias locais.
A grande preocupação, no entanto, continua a ser o balcão. Mesmo com pouco tempo no ramo, ele já percebeu que um dos maiores problemas enfrentados no negócio é lidar com o baixo consumo e a falta de conhecimento. “Aqui a gente comercializa o que as pessoas desconhecem, é preciso informar o modo de preparo, entre outras questões”, disse. Os clientes reconhecem o diferencial da proposta. “As pessoas chegam e dizem que estamos de parabéns por causa do ambiente limpo, e se surpreendem porque não há o cheiro do peixe”, comentou.
O sucesso leva o casal a planejar uma segunda loja, o bairro nobre do Morumbi está na lista. Em paralelo, também devem apostar no delivery e um sushi bar na loja: “É um mercado bastante promissor e apaixonante. Os peixeiros antigos dizem que todo mundo que entra nesse ramo não consegue mais sair. Conheço pessoas que estão há 50 anos e agora as entendo.”

